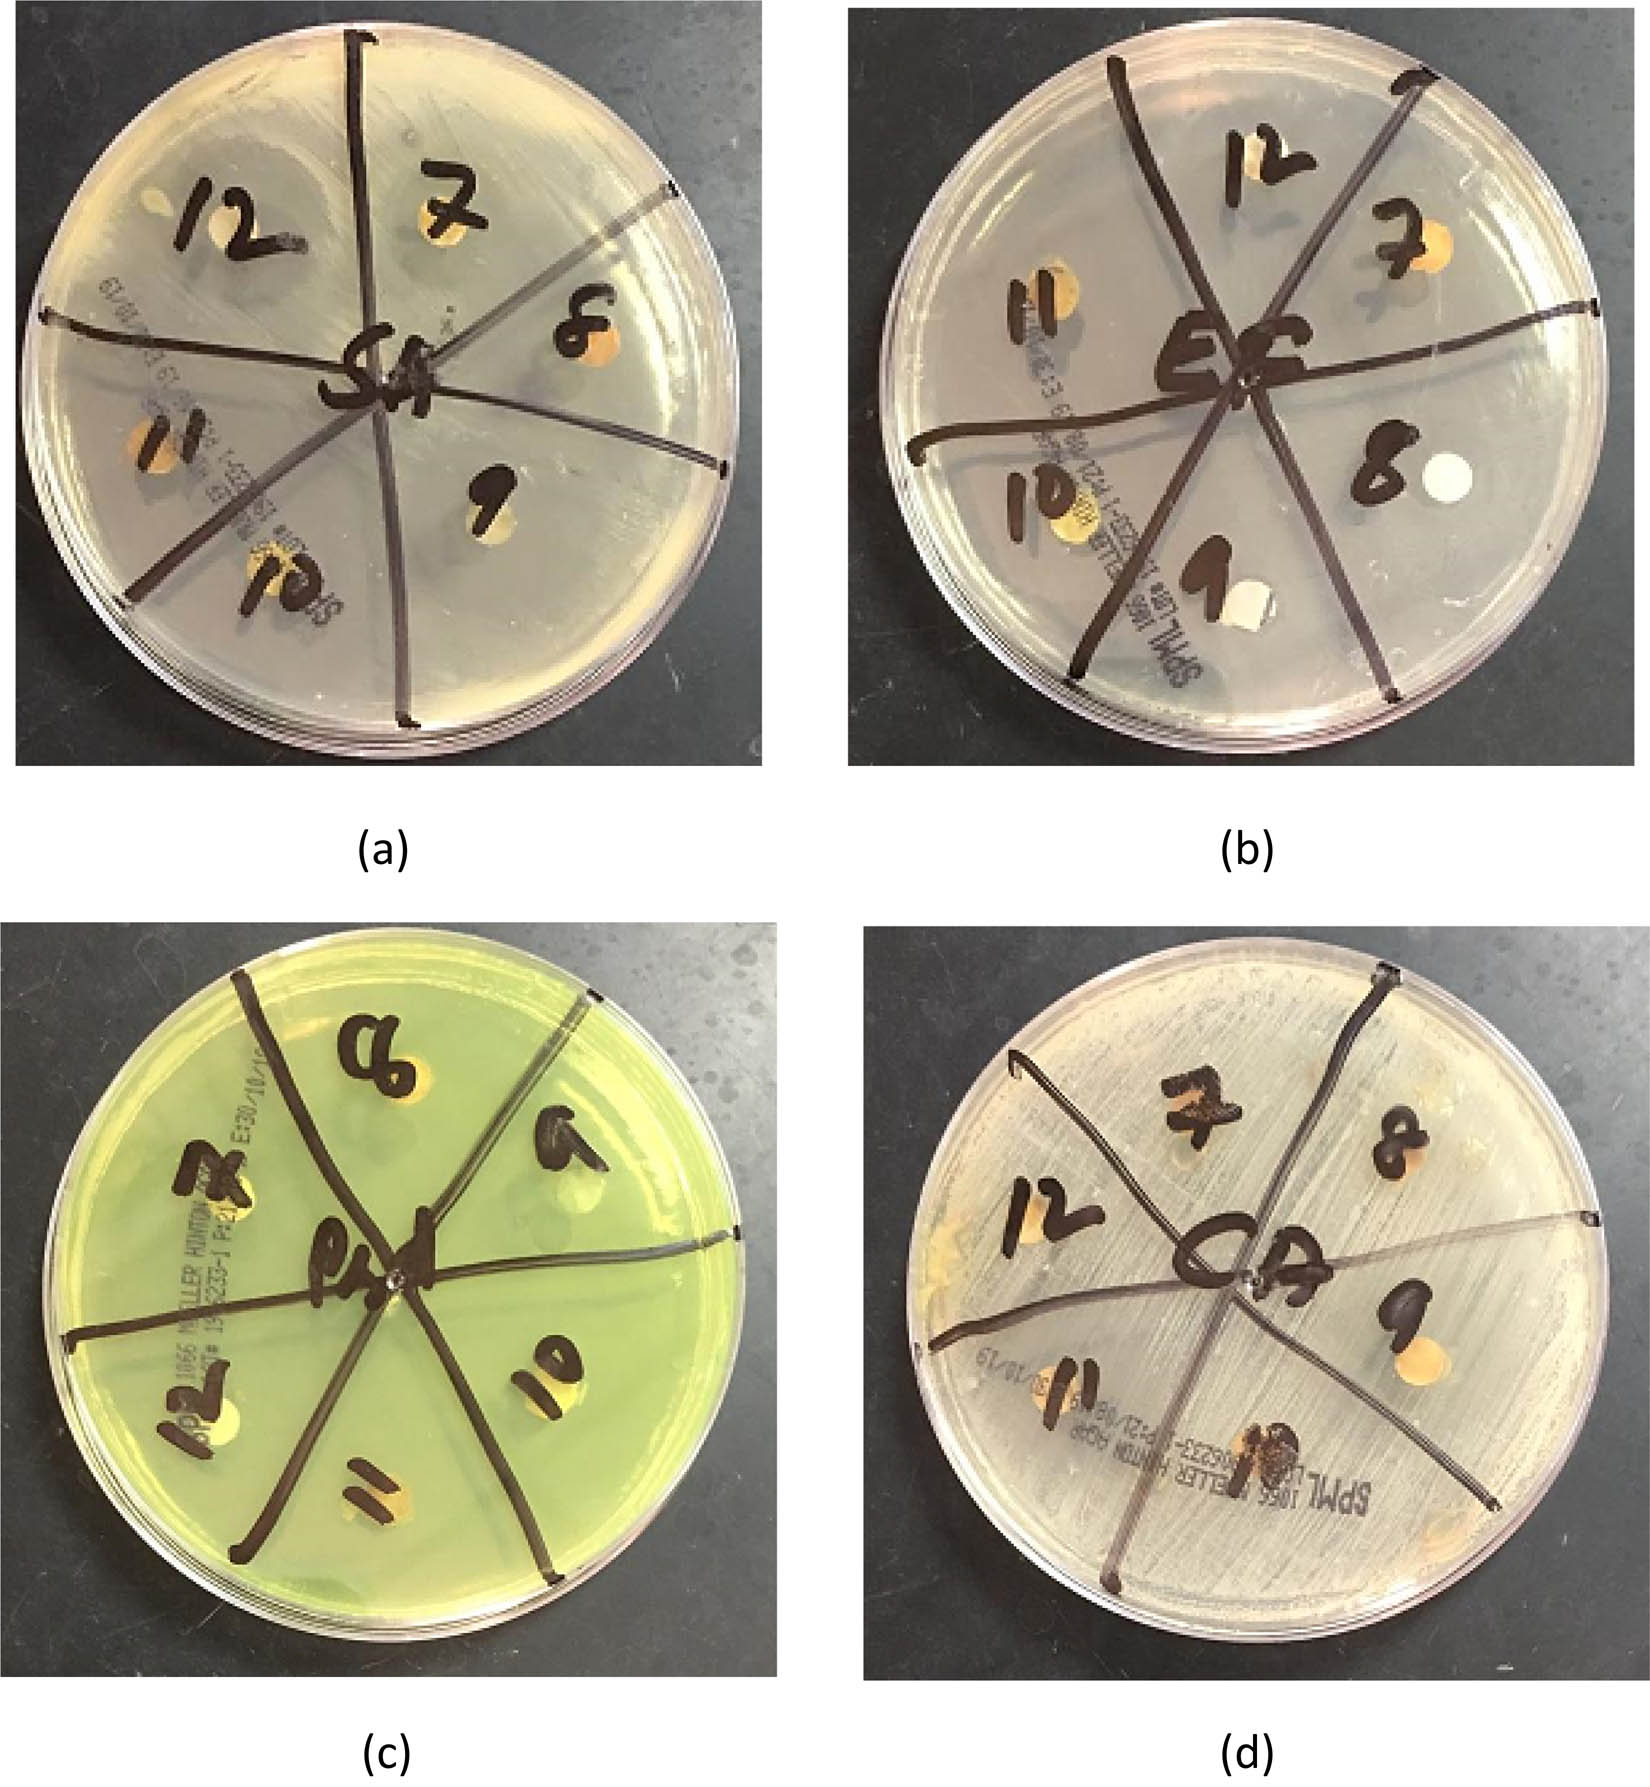
Figure 10 Representative photographs for antibacterial and antifungal tests for each strain used: (a) E. faecalis, (b) E. coli, (c) P. aeruginosa, (d) C. albicans.

Abstract
The purpose of this work was to prepare Schiff base ligands containing quinoline moiety and using them for preparing Cu(ii) and Zn(ii) complexes. Four bidentate Schiff base ligands (SL1–SL4) with quinoline hydrazine scaffold and a series of mononuclear Cu(ii) and Zn(ii) complexes were successfully prepared and characterized. The in vitro antibacterial and antifungal potential experimentation revealed that the ligands exhibited moderate antibacterial activity against the Gram-positive bacterial types and were inactive against the Gram-negative bacteria and the fungus strains. The metal complexes showed some enhancement in the activity against the Gram-positive bacterial strains and were inactive against the Gram-negative bacteria and the fungus strains similar to the parent ligands. The complex [Cu(SL1)2] was the most toxic compound against both Gram-positive S. aureus and E. faecalis bacteria. The in silico physicochemical investigation revealed that the ligand SL4 showed highest in silico absorption (82.61%) and the two complexes [Cu(SL4)2] and [Zn(SL4)2] showed highest in silico absorption with 56.23% for both compounds. The in silico pharmacokinetics predictions showed that the ligands have high gastrointestinal (GI) absorption and the complexes showed low GI absorption. The ligands showed a good bioavailability score of 0.55 where the complexes showed moderate to poor bioavailability.
1 Introduction
The chemical compounds containing azomethine group called Schiff bases are an excellent class of ligands and are widely used in coordination chemistry. These chemicals have the ability to react with metal ions producing versatile coordination metal complexes, which have wide applications in different fields [1,2]. It is well established in the literature that the presence of the main functional azomethine group (–CH═N–) in the structure of the Schiff bases is a characteristic feature of these compounds and responsible for their various biological potentials and medicinal actions [3,4].
The Schiff bases containing heterocyclic systems have been a fertile area of research for a long period, and there is a vast literature work on Schiff base complexes comprising heterocyclic structures [5]. The complexes derived from quinoline and quinoline derivatives currently attracted the interest among the Schiff base ligands containing heterocyclic ring. The Schiff bases containing quinoline nucleus have more favored attention mainly due to their potential applications in the medicinal field [6,7,8,9,10].
In view of the facts and the important features of Schiff bases containing quinoline moiety as reported in the literature, we encouraged and focused our investigation to design new ligand compounds with such structures. The suggested Schiff base ligands were derived from 2-(quinolin-8-yloxy)acetohydrazide as a primary amine condensed with different aromatic aldehydes such as salicylaldehyde, o-vaniline, 2-hydroxy-1-naphthaldehyde, and 3-pyridinecarbaldehyde. The synthesized ligands were used further to synthesize metal complexes with copper and zinc metal ions. All synthesized compounds were investigated in vitro for their antibacterial and antifungal potentials. Moreover, the prepared compounds were subjected to in silico physicochemical and pharmacokinetics investigation to predict the absorption, distribution, metabolism, and elimination (ADME) drug-likeness properties.
The targeted compounds were prepared successfully, and their antimicrobial potential was comparatively weak.
2 Materials and methods
2.1 Materials
All starting chemicals and solvents used in this study were of reagent grade, obtained from Sigma-Aldrich, Luba, and BDH Chemical Companies. The primary aromatic amine compound 2-(quinolin-8-yloxy)acetohydrazide was synthesized from 8-hydroxy quinoline in our laboratory following the literature reported method [11,12].
2.2 Instrumentation and physical measurements
For characterization of the prepared ligands and their metal complexes, we used different physical and spectroscopic analysis techniques. The melting points were measured utilizing the electro-thermal IA9100 digital melting point apparatus. The micro-elemental analysis was determined using the Thermo Fisher Scientific CHN/S/O analyzer instrument (Leco Model VTF-900 CHN-S-O 932 version 1.3x USA). Metal percentage in the complexes was determined using Inductively Coupled Plasma Optical Emission Spectrometry (ICP-OES). For this purpose, the instrument used was Thermo Fisher Scientific ICP-7000 plus Series ICP-OS spectrophotometer (USA). Mass spectroscopy was obtained from the Thermo Fisher Scientific-LCQ fleet ion trap mass spectrometer (USA) using the electrospray ionization (ESI) method.
UV-visible absorption spectra measurements were performed on Thermo Fisher Scientific Evolution 300 UV-visible double beam spectrophotometer (USA) using 0.001 M dimethyl sulfoxide (DMSO) solution. FT-IR spectra were obtained in the range 400–4,000 cm−1 on Thermo Fisher Scientific Nicolet iS50 FT-IR spectrophotometer (USA) using attenuated total reflection (ATR) method for direct measurement of the IR spectrum for the powder solid samples. 1H and 13C NMR spectra of the ligands and the metal complexes were recorded via Bruker 400 MHz spectrometer (Germany) using DMSO as the solvent at the Faculty of Science, Suhag University, Egypt. The magnetic susceptibilities of complexes were measured by the Gouy method at room temperature using the Sherwood scientific magnetic susceptibility balance (UK) and using distilled water as the calibrant. The measurements were carried out at the Central Laboratory, Faculty of Science, Cairo University, Egypt. Molar conductance of the metal complexes was measured using the Fisher Scientific AP85 Portable Waterproof PH/conductivity meter (Italy). The molar conductance measurements were performed using 0.001 M solutions of the complexes in DMSO at room temperature. Thermal analysis measurements were performed on Shimadzu thermo-analyzer TG-50H (Japan) in a nitrogen atmosphere and rate flow 20.0 mL/min at a heating rate of 10°C/min in the temperature range 25–1,000°C.
2.3 Preparation of 2-(quinolin-8-yloxy)actohydrazide precursor
The main primary amine compound 2-(quinolin-8-yloxy)acetohydrazide (Figure 1) was prepared in two steps following reported method by the reaction of 8-hydroxyquinoline (0.02 mol) with ethyl chloroacetate (0.02 mol) in dry acetone to get ethyl ester of o-alkylated 8-hydroxyquinoline and then reacted with hydrazine hydrate (0.04 mol). The yield was 81.3% and the melting point measured 138°C similar to the reported one [11,12,13].

Structure of 2-(quinolin-8-yloxy)acetohydrazide.
2.4 General method for synthesis of the Schiff base ligands (SL1–SL4)
The organic Schiff base ligands (SL1–SL4) were synthesized according to the standard methods [14]. The primary amine 2-(quinolin-8-yloxy)acetohydrazide (0.01 mol) was dissolved in ethanol and mixed with the stoichiometric quantity (0.01 mol) of the aldehydic compound dissolved in ethanol with continuous stirring using a hot-stage magnetic stirrer and refluxing the mixture for a proper time of 1–2 h. Completion of reactions was checked with thin layer chromatography (TLC), and the obtained products after cooling to room temperature were filtered, dried, and finally purified by recrystallization. Physical characteristics, elemental analysis, and percentage of yield for each prepared Schiff base are detailed in the following sections.
2.4.1 Synthesis of N′-[(E)-(2-hydroxyphenyl)methylidene]-2-[(quinolin-8-yl)oxy]acetohydrazide (SL1)
For the preparation of SL1 (Figure 2), a mixture of 2-(quinolin-8-yloxy)acetohydrazide 0.01 mol was reacted with 0.01 mol salicylaldehyde in ethanol with stirring using a hot-stage magnetic stirrer and refluxed for nearly 2 hours. The whitish-yellow solid precipitate was filtered, washed with ethanol, dried, and finally recrystallized in hot ethanol. The yield obtained was 82%, and the measured melting point was 132°C. Elemental analysis for C18H15N3O3: cal. (found), %C 67.34 (67.02), %H 4.67 (4.77), %N 13.08 (13.36), and %O 14.95 (14.63).

Structure of SL1 ligand.
2.4.2 Synthesis of N′-[(E)-(2-hydroxy-3-methoxyphenyl) methylidene]-2-[(quinolin-8-yl)oxy]acetohydrazide (SL2)
For the preparation of SL2 (Figure 3), 0.01 mol of 2-(quinolin-8-yloxy)acetohydrazide was mixed with 0.01 mol o-vaniline (2-hydroxy-3-methoxybenzaldehyde) in 30 mL ethanol in a round-bottomed flask. The mixture was refluxed with continuous stirring using a hot-stage magnetic stirrer for nearly 2 hours. The off-white solid precipitate was filtered, washed with ethanol, dried, and finally recrystallized in hot ethanol. The yield obtained was 89%, and the measured melting point was 117°C.

Structure of SL2 ligand.
Elemental analysis for C19H17N3O4: cal. (found), %C 65.01 (64.95), %H 4.84 (4.71), %N 11.97 (12.22), and %O 18.23 (17.86).
2.4.3 Synthesis of N′-[(E)-(2-hydroxynaphthalen-1-yl)methylidene]-2-[(quinolin-8-yl)oxy]acetohydrazide (SL3)
SL3 (Figure 4) was synthesized by condensation reaction using 0.01 mol of 2-(quinolin-8-yloxy)acetohydrazide and mixed with 0.01 mol 2-hydroxy-1-naphthaldehyde in 30 mL ethanol in a round-bottomed flask. The mixture was refluxed with continuous stirring using a hot-stage magnetic stirrer for nearly two and a half hours. The yellow solid precipitate was filtered, washed with ethanol, dried, and finally recrystallized in hot ethanol. The yield obtained was 94%, and the measured melting point was 180°C.

Structure of SL3 ligand.
Elemental analysis for C22H17N3O3: cal. (found), %C 71.22 (71.63), %H 4.58 (4.54), %N 11.32 (11.59), and %O 12.94 (12.64).
2.4.4 Synthesis of N′-[(E)-(pyridin-3-yl)methylidene]-2-[(quinolin-8-yl)oxy]acetohydrazide (SL4)
SL4 (Figure 5) was synthesized by condensation reaction using 0.01 mol of 2-(quinolin-8-yloxy)acetohydrazide as a primary amine and mixed with 0.01 mol pyridine-3-carboxaldehyde as an aldehydic compound in 30 mL ethanol in a round-bottomed flask. The reaction mixture was refluxed with continuous stirring using a hot-stage magnetic stirrer for nearly 2 hours. The yellowish-white (beige) solid precipitate was filtered, washed with ethanol, dried, and finally recrystallized in hot ethanol. The yield obtained was 78%, and the measured melting point was 105°C.

Structure of SL4 ligand.
Elemental analysis for C17H14N4O2: cal. (found), %C 66.72 (66.33), %H 4.58 (4.85), %N 18.30 (18.71), and %O 10.46 (10.12).
2.5 General procedure for preparation of metal complexes
The targeted Cu(ii) and Zn(ii) metal complexes were prepared by the general reported procedure [14]. A solution of metal salt dissolved in ethanol was mixed gradually with the ethanolic solutions of the Schiff bases (SL1–SL4) obtained as mentioned before in 1:2 (metal to ligand) molar ratio. The reaction mixture was refluxed with continuous stirring using a hot-stage magnetic stirrer for 4–6 h at nearly 90°C. The precipitated compounds obtained were separated by filtration, washed with hot ethanol, and finally with diethyl ether. The compounds were dried in open air; the yield, color, mass spectra, and elemental analysis are given later. The melting points for all metal complexes were above 300°C. The elemental analysis and physical characteristics of the prepared complexes are presented in Table 1.
Physical properties and elemental analysis of the synthesized Schiff base complexes
| Metal complex | Mol. formula | Mol. wt. | Color | Yield (%) | Mass spectra (m/z) | Elemental analysis calculated (found) (%) | ||||
|---|---|---|---|---|---|---|---|---|---|---|
| C | H | N | O | Metal | ||||||
| [Cu(SL1)2] | CuC36H28N6O6 | 703.5 | Green | 58.8 | 704.00 | 61.41 (61.82) | 3.98 (4.15) | 11.94 (11.63) | 13.64 (13.73) | 9.03 (8.86) |
| [Zn(SL1)2] | ZnC36H28N6O6 | 705.38 | Off-white | 72.99 | 705.08 | 61.24 (60.98) | 3.96 (4.24) | 11.90 (11.76) | 13.60 (13.66) | 9.26 (9.11) |
| [Cu(SL2)2] | CuC38H32N6O8 | 655.55 | Turquoise green | 68.13 | 763.92 | 69.55 (70.00) | 4.88 (5.12) | 12.81 (12.34) | 19.52 (19.16) | 9.69 (9.62) |
| [Zn(SL2)2] | ZnC38H32N6O8 | 765.38 | Yellowish-white | 79.89 | 765.33 | 69.36 (69.85) | 4.86 (4.71) | 12.77 (12.70) | 19.47 (19.83) | 9.94 (9.70) |
| [Cu(SL3)2] | CuC44H32N6O6 | 803.55 | Light green | 87.03 | 802.33 | 65.70 (66.02) | 3.98 (4.12) | 10.45 (10.22) | 11.94 (11.50) | 7.90 (8.14) |
| [Zn(SL3)2] | ZnC44H32N6O6 | 805.38 | Yellowish-white | 87.04 | 805.42 | 65.55 (65.68) | 3.97 (4.16) | 10.42 (10.36) | 11.91 (12.35) | 8.11 (8.26) |
| [Cu(SL4)2] | CuC34H26N8O4 | 673.55 | Light brown | 76.32 | 672.17 | 60.57 (60.95) | 3.86 (4.12) | 16.63 (16.27) | 9.50 (9.17) | 9.43 (9.40) |
| [Zn(SL4)2] | ZnC34H26N8O4 | 675.38 | Whitish-yellow | 58.5 | 675.08 | 60.41 (60.32) | 3.84 (4.06) | 16.58 (16.92) | 9.47 (9.11) | 9.68 (9.44) |
2.6 Antimicrobial activity assessment – in vitro experimentation
The microbial susceptibility of the free organic ligands and their Cu(ii) and Zn(ii) metal complexes was assessed for their antimicrobial capacity against different pathogenic Gram-negative and Gram-positive bacterial strains and fungal strains. The two Gram-negative bacterial strains used in the experimentation were P. aeruginosa (ATCC 27853) and E. coli (ATCC25922), and the two Gram-positive bacterial strains used in the experimentation were S. aureus (ATCC 25923) and E. faecalis (ATCC 29212). For antifungal experimentation potentials, we used the common pathogenic yeast C. albicans (ATCC10231). The assessment experiments were performed in vitro at the Department of Clinical Microbiology, Blood Bank Centre, Al-Baha City, KSA. The method followed was agar disk-diffusion assessment method according to the Clinical and Laboratory Standards Institute (CLSI) [15]. Muller Hinton Agar was used as a growth medium for bacterial strains, while Sabouraud dextrose agar nutrient was used as a microbiological growth medium for fungal strains. Stock solutions of the examined compounds were prepared by dissolving 0.02 g of each compound in 5.0 mL DMSO solvent and used for experimental tests. DMSO solvent was used as the negative control. The common antibacterial amoxicillin and the antifungal fluconazole drugs were used as references for comparison. The zones of complete inhibition (in millimeters) after the incubation period were measured around every compound, which indicates the lethality of the tested compound on the microbial microorganisms in question.
2.7 In silico predictions
The prepared ligands and their metal complexes were subjected to in silico physicochemical investigation, and the number of rotatable bonds, lipophilicity, and topological polar surface area (TPSA) were calculated to understand the drug transport properties. In silico % age absorption was calculated using the reported formula [(%ABS = 109 − (0.345 × TPSA)] [16,17]. In addition, the in silico pharmacokinetic predictions were carried out to predict the absorption, distribution, metabolism, and elimination (ADME) for the targeted ligands, and their corresponding metal complexes were determined by Swiss ADME web interface (http//www.sib.swiss) [18]. The Lipinski, Ghose, Veber, Egan, and Muegge rules were applied to predict whether the targeted compounds are likely to be bioactive [19].
Ethical approval: The conducted research is not related to either human or animal use.
3 Results and discussion
3.1 Synthesis and characterization
The main purpose of this research work was to synthesize and characterize new Schiff base ligands incorporating quinoline moiety and to use them for preparing metal complexes with the transition metal ions Cu2+ and Zn2+. To achieve this goal, the key primary amine compound 2-(quinolin-8-yloxy)acetohydrazide containing quinoline moiety was selected and synthesized in the laboratory following the reported procedure [11,12,13]. The structure of the key compound was confirmed before proceeding for the next step. Furthermore, the synthesized primary amine 2-(quinolin-8-yloxy)acetohydrazide was coupled with different aromatic aldehydes such as salicylaldehyde, o-vaniline, 2-hydroxy-1-naphthaldehyde, and pyridine-3-carboxaldehyde in (1:1) stoichiometric ratio to produce four different quinoline-hydrazone Schiff base ligands (SL1–SL4).
3.1.1 Characterization of the Schiff base ligands
The isolated Schiff bases were purified by recrystallization using hot ethanol and were in good yields (78–94%). They were mostly yellow colored and were soluble in hot ethanol, N,N-dimethylformamide (DMF), and dimethyl sulfoxide (DMSO). The isolated Schiff base ligands were characterized, and the proposed structures were confirmed before proceeding for the preparation of the targeted Cu(ii) and Zn(ii) metal complexes step. The elemental analysis results for C, H, N, and O found were in good agreement with the theoretically calculated percentage values for the proposed molecular formulae, in favor of the expected structures of the Schiff base ligands. The obtained mass spectra (m/z) for each of the prepared ligand compounds (SL1–SL4) were also in agreement with the molecular formulae of the prepared Schiff bases.
The IR spectrum of the organic Schiff base compounds exhibited characteristic peaks (Table 2), which were helpful in proving the proposed structures of the ligands. The sharp bands appeared at 1,500, 1,502, 1,504 and 1,505 in the spectrum of the ligands SL1–SL4, respectively, designed to the characteristic azomethine group (–CH═N–), which indicates the formation of the Schiff base ligands [20]. The presence of the aromatic (–OH) group in the spectrum of the ligands exhibited peaks at 3,500, 3,513, 3,570, and 3,606 cm−1, respectively [21]. The intense bands observed in the range 1,225–1,255 in the IR spectrum of the ligands (SL1–SL3) are due to the phenolic C–O linkage [22]. The sharp transmission bands at 1,660, 1,665, 1,685, and 1,671 cm−1 in the spectra of SL1, SL2 SL3, and SL4, respectively, are due to the presence of the stretching carbonyl C═O group [9,12,23]. Weak transmission bands observed in the range 2,985–2,988 cm−1 may be assigned to the –N–H amide group [9,23]. The transmission bands observed at 1,115, 1,114, 1,110, and 1,112 cm−1 in the spectra of SL1, SL2 SL3, and SL4, respectively, can be assigned to the –N–N– linkage [24].
Important characteristic IR bands (cm−1) of the ligands and metal complexes
| Compounds | νC═N | νOH | νC–O (phenolic) | νC═O (carbonyl) | NN—H | νM–N | νM–O | ν–N–N– |
|---|---|---|---|---|---|---|---|---|
| SL1 | 1,500 | 3,500 | 1,225 | 1,660 | 3,050 | — | — | 1,115 |
| SL2 | 1,502 | 3,513 | 1,255 | 1,655 | 3,045 | — | — | 1,114 |
| SL3 | 1,504 | 3,570 | 1,242 | 1,685 | 2,995 | — | — | 1,110 |
| SL4 | 1,505 | 3,606 | — | 1,671 | 2,988 | — | — | 1,112 |
| [Cu(SL1)2] | 1,534 | — | 1,252 | 1,653 | 3,012 | 480 | 586 | 1,112 |
| [Zn(SL1)2] | 1,550 | — | 1,261 | 1,659 | 3,062 | 484 | 571 | 1,114 |
| [Cu(SL2)2] | 1,541 | — | 1,212 | 1,684 | 2,988w | 479 | 583 | 1,110 |
| [Zn(SL2)2] | 1,543 | — | 1,223 | 1,653 | 3,015 | 456 | 577 | 1,115 |
| [Cu(SL3)2] | 1,553 | — | 1,211 | 1,662 | 3,021w | 451 | 532 | 1,114 |
| [Zn(SL3)2] | 1,557 | — | 1,218 | 1,684 | 3,050 | 462 | 569 | 1,113 |
| [Cu(SL4)2] | 1,545 | — | — | 1,670 | 3,010 | 451 | 568 | 1,112 |
| [Zn(SL4)2] | 1,540 | — | — | 1,663 | 3,024w | 488 | 542 | 1,127 |
w = weak band.
The observed UV-visible absorption spectra for the free organic Schiff base ligands (SL1–SL4) show two main bands. The first observed at lower wavelength bands at 295, 284, 262, and 301 nm in the spectrum of the ligands SL1, SL2, SL3, and SL4, respectively, that can be assigned to π → π* transitions within the benzene and quinoline rings [25,26]. The second bands were observed at 324, 326, 322, 317 nm in the spectrum of the ligands SL1, SL2, SL3, and SL4, respectively, which may involve π → π* and n → π* transitions of the (–C═N–) group [26].
In the 1H NMR Spectra of all the Schiff base ligands (SL1–SL4), the imine protons were observed at 8.58–8.98 ppm as a singlet. Moreover, the peaks at 11.05–12.23 ppm, which are singlets, can be attributed to aromatic –OH protons in the ligand SL1, SL2, and SL3 [27]. This shift in the position of the singlet may be due to the possibility effect of the formation of intramolecular hydrogen bonding interaction. The singlets appeared in the range of 12.18–12.52 ppm in the 1H NMR spectrum of all Schiff base ligands are due to the –NH– linkage [28]. The peaks due to the aromatic hydrogens appeared in the range of 7.00–8.98 ppm [29].
In 13C NMR spectra of the ligands SL1, SL2, SL3, and SL4, the peaks appeared at 148.75, 148.48, 147.62, and 145.69 ppm, respectively, are assigned to the carbon atom of the azomethine group [27]. The singlet peaks observed in the range of 164.81–169.57 ppm is due to the carbon atom of the C═O group [30]. Moreover, the peaks observed in the region 109.00–154.49 ppm are because of the carbon atoms of the aromatic ring [9].
3.1.2 Synthesis and characterization of metal complexes
Copper(ii) and Zinc(ii) from the first transition elements series of the d-block elements were chosen for the synthesis of the designed metal complexes in this research project. These metals are familiar, important metals and form interesting coordination compounds.
The targeted coordination metal complexes were prepared successfully by reacting to the metal salts of the selected metals with the prepared Schiff base ligands (SL1–SL4) in (1:2) stoichiometric ratio according to the described template method. The separated metal complexes were stable solids at room temperature and nonhygroscopic. They were solids insoluble in common organic solvents but soluble in DMF and DMSO. They were purified by recrystallization from hot DMF and DMSO solvents. All prepared metal complexes had high melting points (above 300°C).
The elemental analysis measurements suggested 1:2 metal to ligand stoichiometric ratio forming tetra-coordinate monomeric Cu(ii) and Zn(ii) metal complexes. The measured percentages of the carbon, hydrogen, nitrogen, oxygen, and metal ion are in agreement with the calculated ones according to the suggested structure of the complexes as shown in Figure 6(a–d). The Schiff base quinoline acetohydrazone ligands containing NO coordination sites behave as monobasic bidentate ligands. The general formula for the prepared complexes suggested to be [M(SL1–4)2] for all metal complexes

Structure of the synthesized complexes with (a) SL1, (b) SL2, (c) SL3, and (d) SL4 where M = Cu(ii) or Ni(ii).
According to the above-proposed structures, the prepared Cu(ii) and Zn(ii) complexes are suggested to be mononuclear complexes. The ligands SL1–SL3 bind to metal ions through the nitrogen atom of the azomethine (–CH═N–) group and the oxygen atom of the phenolic (–OH) group forming square planar geometry. Moreover, the bidentate Schiff base ligands SL1, SL2, and SL3 forms six-membered chelate rings at the Cu(ii) and Zn(ii) acceptor centers. The ligand SL4 binds to metal ions through the N atom of –C═N– group and the O atom of the carbonyl group forming square planar geometry. The bidentate SL4 ligand forms a five-membered ring at the metal acceptor center.
To prove the proposed structures for the prepared metal complexes, we performed different analytical techniques. Mass spectrometry analysis was carried out to help in quantifying and structure elucidation of the obtained complexes and confirm the molecular weights. The measured (m/z) peaks indicated that the observed molecular peaks for all prepared metal complexes are equivalent to the theoretically calculated formula weights according to the proposed structures. These observations support and prove the suggested structures for the prepared metal complexes shown in Figure 6(a–d).
The comparison between the IR spectral data of the free organic ligands (SL1–SL4) and that of the corresponding Cu(ii) and Zn(ii) metal complexes demonstrate that the ligands were binding to the metal ions. The coordination of the ligands through the nitrogen atom of the azomethine group was indicated through the shift (blue shift) of the νC═N band in the IR spectrum of the complexes when compared with the free organic ligands. This also was supported by the appearance of the new weak band in the spectrum of the metal complexes at the range of 437–488 cm−1 attributed to the formation of M–N bonds [1]. The formation of M–N bond leads to the weakening of the C═N band due to the donation of electrons from the nitrogen atom to the vacant d-orbitals in the metal atoms, which causes the shift of the azomethine band in the metal complexes [16].
The bands (3,500, 3,513, 3,570, and 3,606 cm−1) shown in the IR spectrum of the free Schiff bases (SL1–SL3) due to the phenolic (νOH) group were disappeared in the IR spectrum of the corresponding Cu(ii) and Zn(ii) complexes. This is a sign of the binding of the oxygen atom of the phenolic group to the metal atoms [22,31]. Moreover, the intense bands observed in the IR spectrum of the ligands (SL1–SL3) due to the phenolic C–O linkage were shifted and appeared in the range of 1,211–1,265 cm−1 is another proof for the involvement of the OH group in bonding with the metal ions [22]. In addition, a weak band was observed in the IR spectrum of these complexes at the range of 542–595 cm−1 which is assigned to the νM–O mode, evidence for the formation of M–O bonds [32,33].
It was also observed that the band 1,671 cm−1 due to the νC═O of the carbonyl group in the IR spectrum of SL4 ligand was shifted slightly in the spectrum of the corresponding metal complexes, which indicate the binding of the oxygen atom to the metal ions [33].
The most important bands observed in the IR spectrum of the metal complexes are shown in Table 2.
The UV-visible and magnetic moment susceptibility (μeff) data are helpful tools to deduce the nature of the ligand field around the metal ion and the geometry of the obtained metal complexes. The observed UV-visible transmission bands for the prepared Cu(ii) and Zn(ii) complexes are shown in Table 3. The UV-visible spectra indicate that there is a relative shift to lower wavelengths (bathochromic shift) of the transmission bands due to π–π* and n–π* transitions that observed in the spectrum of the free prepared Schiff base ligand. This observation may be because of the coordination of the ligands to the metal core, which causes a change in the distribution of electrons between the ligands and the metal ions [25,26,34,35].
UV-visible transmission bands and μeff values for the metal complexes
| Compound | Transmission bands (λmax in nm) | Magnetic moment μeff (B.M.) |
|---|---|---|
| [Cu(SL1)2] | 305, 385, 661 | 1.961 |
| [Zn(SL1)2] | 277, 418, 685 | Diamagnetic |
| [Cu(SL2)2] | 313, 390, 675 | 2.261 |
| [Zn(SL2)2] | 305, 415, 610 | Diamagnetic |
| [Cu(SL3)2] | 321, 377, 650 | 1.924 |
| [Zn(SL3)2] | 273, 428, 622 | Diamagnetic |
| [Cu(SL4)2] | 345, 374, 648 | 1.906 |
| [Zn(SL4)2] | 269, 433, 612 | Diamagnetic |
The discussion for each metal complexes is discussed in the following sections.
3.1.3 Cu(ii) metal complexes
The observed UV-visible spectra of the synthesized mononuclear copper(ii) complexes showed transmission bands in the range λmax = 648–675 nm, which may be accountable for the 2B1g → 2A1g transitions that are consistent with square-planar geometry around the Cu(ii) centers [36,37]. Moreover, the magnetic moment values (Table 3) were between 1.906 and 2.261 BM which lies within the permissible values reported for one unpaired electron, and it is an evident that supports the square-planar geometry of Cu(ii) complexes [37]. This geometry is achieved through the coordination of two bidentate ligands (SL1–SL4) to the metal center in trans-geometry with respect to each other as shown in Figure 6(a–d).
3.1.4 Zn(ii) complexes
The transmission bands observed in the range 269–277 nm in the UV-visible spectrum of Zn(ii) complexes can be assigned to the π → π* transitions. The weak bands in the range of 305–318 nm were assigned to n → π* transitions. Moreover, the bands observed in the range 423–438 nm may be attributed to the ligand-to-metal charge transfer transitions [27,38]. The lowest energy bands at the range 610–685 nm were due to the d → d transition of Zn2+. These observations are consistent with square-planar geometry. The observed magnetic moment (Table 3) for all Zn(ii) complexes were diamagnetic, which is in support of the square-planar geometry [27,38].
The four-coordinated mononuclear complexes of Zn(ii) are achieved through the coordination of the bidentate (SL1–SL4) ligands to the metal center in trans-geometry with respect to each other as shown in Figure 6(a–d). The coordination is through two N atoms and two oxygen atoms from two same Schiff base ligands in a square-planar geometry.
The 1H NMR analysis was further performed to achieve concrete evidence of the binding of the Cu2+ and Zn2+ to the ligands. Upon complexation, the peaks due to the proton of the imine group in the Schiff base ligands were showed field up shift slightly by Δδ = 0.40–0.80 ppm. The singlet peaks due to the phenolic proton in the 1H NMR spectra of SL1, SL2, and SL3 were disappeared indicating the deprotonation of this group. These observations proved that the N atom of the azomethine
Thermal analysis studies of some prepared metal complexes were investigated at the heating rate of 10 (°C/min) under the nitrogen atmosphere from room temperature to 800°C. These thermogravimetric studies are helpful tools and good supports in the characterization of the prepared metal complexes.
The results of representative TG/DTA plots of the analyzed metal complexes are shown in Figure 7 and 8. The results show good harmony with the proposed chemical structures suggested from the analytical data as discussed earlier. It is obvious from the decomposition pattern that the studied metal complexes were decomposed in three successive stages. The TGA curves of anhydrous complexes do not display any mass losses up to 260°C, which indicate the thermal stability of the metal complexes and confirm the absence of water molecules in the complex structures. In Figure 7, the first step for the complex [Zn(SL1)2] (molecular weight = 706.3) started decomposition between 256 and 331°C and weight loss observed was 28.416% which is corresponding to two molecules of the salicylaldehyde part from the ligand (i.e., C14H12) (calculated weight percentage 30.02%) may be due to breaking the azomethine linkage during heating. The second step of decomposition was between 421.02 and 569.41°C with an observed weight loss of 54.243%, which can correspond to the ligand and aromatic ring (C6H4) (calculated weight percentage 54.44%). The third step on further heating above 600°C, metal complexes decompose to stable zinc oxide. In Figure 8, the first step for the decomposition of [Zn(SL3)2] (molecular weight = 806.15) started decomposition between 230 and 310°C and weight loss observed was 52.37% which is corresponding to two molecules of the amine part (i.e., C22H18O4N6) from the organic ligand (calculated weight percentage 53.35%). In the second step, the observed weight loss was 44.83% which corresponds to the organic ligand (C22H17N3O3) (calculated weight percentage = 46.02%). Final step above 630°C decompose the complex to the stable zinc oxide. In the DTA curve of the metal complexes, the heat flow in the 90–600°C temperature range was shown as endothermic peaks.
![Figure 7 TGA–DTA curves of [Zn(SL1)2].](/document/doi/10.1515/chem-2020-0085/asset/graphic/j_chem-2020-0085_fig_007.jpg)
TGA–DTA curves of [Zn(SL1)2].
![Figure 8 TGA–DTA curves of [Zn(SL3)2].](/document/doi/10.1515/chem-2020-0085/asset/graphic/j_chem-2020-0085_fig_008.jpg)
TGA–DTA curves of [Zn(SL3)2].
3.2 Molar conductance of the prepared metal complexes
To examine the electrolytic or nonelectrolyte nature of the prepared metal complexes, we measured the molar conductance (Λm) of freshly prepared 1.0 × 10−3 M solutions of the synthesized metal coordination compounds in DMSO at room temperature (24°C). The measured values are presented in Table 4. The molar conductance values obtained were in the range (2.16–35.4 Ω−1 cm2 mol−1) which are considered very low. It is evident from these results that the prepared Cu(ii) and Zn(ii) complexes are nonionic in nature (nonelectrolytes). Moreover, it is confirmed that the ligands are involved in the coordination sphere [38,39].
The measured molar conductivity for the metal complexes
| Metal complex | Molar conductance (Ω−1 cm2 mol−1) |
|---|---|
| [Cu(SL1)2] | 7.22 |
| [Zn(SL1)2] | 7.26 |
| [Cu(SL2)2] | 6.32 |
| [Zn(SL2)2] | 27.9 |
| [Cu(SL3)2] | 2.16 |
| [Zn(SL3)2] | 35.4 |
| [Cu(SL4)2] | 12.6 |
| [Zn(SL4)2] | 11.8 |
3.3 In vitro anti-microbial potentials
The free prepared organic ligands (SL1–SL4) and their corresponding Cu(ii), and Zn(ii) metal complexes were assayed in vitro for their potential antibacterial and antifungal activities utilizing the agar disc-diffusion method. The zones of complete inhibition (in millimeters) were measured, and the observations are presented in Table 5 as arithmetic mean values.
Antimicrobial observations for the ligands and their Cu(ii) and Zn(ii) complexes
| Compound | Zone of inhibition (mm) | ||||
|---|---|---|---|---|---|
| Gram-positive bacteria | Gram-negative bacteria | Fungus | |||
| S. aureus | E. faecalis | E. coli | P. aeruginosa | C. albicans | |
| SL1 | 19 | 21 | 7 | 0 | 0 |
| SL2 | 22 | 23 | 0 | 0 | 0 |
| SL3 | 24 | 08 | 0 | 0 | 0 |
| SL4 | 20 | 20 | 0 | 0 | 0 |
| [Cu(SL1)2] | 31 | 32 | 12 | 0 | 0 |
| [Zn(SL1)2] | 18 | 18 | 0 | 0 | 0 |
| [Cu(SL2)2] | 24 | 0 | 0 | 0 | 3 |
| [Zn(SL2)2] | 25 | 28 | 0 | 0 | 0 |
| [Cu(SL3)2] | 25 | 15 | 6 | 0 | 0 |
| [Zn(SL3)2] | 29 | 30 | 13 | 0 | 0 |
| [Cu(SL4)2] | 26 | 11 | 0 | 0 | 0 |
| [Zn(SL4)2] | 9 | 0 | 0 | 0 | 0 |
| Amoxicillin | 40 | 38 | 23 | — | 17 |
| Fluconazole | 36 | 35 | 35 | 37 | 42 |
Key to interpretation: 0 = resistant, less than 10 mm = inactive, 10–15 mm = weakly active, 15–25 mm = moderately active; more than 30 mm = highly active.
The ligands (SL1–SL4) exhibited moderate antibacterial activity against the Gram-positive bacterial types with zones of inhibitions in the range of 8–25 mm. They showed no activity against the Gram-negative bacterial types and the fungal strain too. SL3 ligand compound showed the highest activity when compared with other ligands with a zone of inhibition of 24 mm against S. aureus. Compared to the amoxicillin and fluconazole as standards, the activity of the ligands was much lower.
The corresponding metal complexes, in general, showed some enhancement antibacterial activity against both Gram-positive S. aureus and E. faecalis bacterial strains with zones of inhibitions in the range of 18–32 mm. While similar to the parent ligands, the complexes showed no activity against the Gram-negative bacterial stains and the fungal strain. Few metal complexes showed weak activity against the Gram-negative bacteria E. coli with zones of inhibition less than 15 mm. On comparing between the metal complexes, it was observed that [Cu(SL1)2] was the most toxic compound against the Gram-positive bacteria. [Cu(SL1)2] exhibited activity with zones of inhibition of 31 and 32 mm against S. aureus and E. faecalis, respectively. On comparing the activities of the metal complexes with the standard drugs, the metal complexes exhibited less antibacterial and antifungal activity.
Based on the Tweedy’s chelation theory and Overtone’s permeability principles, the antibacterial enhancement activity of the metal complexes can be interpreted [40]. According to the chelation theory, the coordination of organic ligands with metals reduces the polarity of the metal due to overlap of the orbitals of the ligand with the metal orbitals and the generation of delocalized π-electrons over the entire coordination sphere. This enhances the liposolubity and influences the cell membrane permeability of the metal complexes into the microbial cell [1,40]. This facilitation in the lipophilicity and penetration of the metal complexes inside the microbial cell give rise to adverse effects in the cell environment and enzymes of the cell and further affects the proliferation of the microorganism [20,41]. Moreover, the possibility of the formation of hydrogen bonds through the
The higher activity of the Cu(ii) complexes compared to the Zn(ii) complexes may be interpreted on the stability of these complexes [42].
Figures 9 and 10 show some photographs of the antibacterial and antifungal tests.
![Figure 9 Photographs of some antibacterial tests against S. aureus bacterial strains. (a) Shows some of the active compounds 8 = SL3, 10 = [Zn(SL3)2] and 11 = [Cu(SL3)2]; (b) shows the activity of compound 14 = [Cu(SL1)2].](/document/doi/10.1515/chem-2020-0085/asset/graphic/j_chem-2020-0085_fig_009.jpg)
Photographs of some antibacterial tests against S. aureus bacterial strains. (a) Shows some of the active compounds 8 = SL3, 10 = [Zn(SL3)2] and 11 = [Cu(SL3)2]; (b) shows the activity of compound 14 = [Cu(SL1)2].
Representative photographs for antibacterial and antifungal tests for each strain used: (a) E. faecalis, (b) E. coli, (c) P. aeruginosa, (d) C. albicans.
3.4 In silico prediction
New drug discovery and development demand considerable facilities, materials, and time. For this reason, theoretical investigations have a major role in reducing these factors and predicting the possibility of prospective drug applications. It is not sufficient for a chemical to show in vitro excellent biological activities, but in addition, it is required to satisfy the pharmacokinetic parameters ADME. These parameters can be validated by the in silico investigations through computing the physicochemical criteria.
3.4.1 Physicochemical properties
The pharmacological or therapeutic effect is related to the influence of various physicochemical properties of the chemical on the biomolecules that it interacts with. Different physicochemical parameters of a drug candidate play a crucial role in their pharmacokinetic behavior [43]. In view of this, their calculation and measurement help in prioritizing compounds for screening as an efficient drug candidate and enable preliminary decisions in drug discovery [44]. The prepared ligands and their metal complexes were subjected to in silico physicochemical studies such as number of rotatable bonds, hydrogen bond acceptor, hydrogen bond donor, molecular reactivity, water-solubility, lipophilicity, and topological polar surface area (TPSA), which were calculated for understanding the drug transport properties. All results obtained are presented in Table 6. The results of in silico absorption percentage calculations indicated that the percentage of absorption was in the range of 76.90–82.61% among ligands, where the ligand SL4 was the highest with an absorption percentage of 82.61%. The in silico absorption percentage (42.84–56.23) among complexes observations showed that the complexes [Cu(SL4)2] and [Zn(SL4)2] showed the highest absorption percentage with the value of 56.23% for both complexes. On comparing the ligands and their corresponding metal complexes, it is clear that the ligands showed a much higher absorption percentage. Moreover, the obtained TPSA values for the ligands were below 140 Å2 (the accepted limit of polar surface area), indicating that ligands had considerable permeability into the cellular plasma membrane [45]. While the TPSA values for the examined metal complexes were very high (>140 Å2) marking low permeability into the cellular plasma membrane. The log S (that is the coefficient of solubility determined by the estimated solubility (ESOL) method computed on Swiss ADME) for many known drugs available in the market showed values more than −4.00 [45]. In our investigation, the obtained values of log S (Table 6) for the ligands SL1, SL2, and SL4 were little more than −4.00, indicating that these compounds are considered moderate soluble. While SL2 was having a value of (−4.81) which is less and hence this compound considered insoluble. In the case of the metal complexes, the log S values are much less than (−4.00), and hence, the metal complexes are considered highly insoluble.
Physicochemical properties of the ligands and their complexes
| Compound no. | Fraction Csp3 a | No. of rotatable bonds | HBAb | HBDc | MilogPd | Molar refractivity | ESOL log Se | TPSAf | In silico % absorption |
|---|---|---|---|---|---|---|---|---|---|
| SL1 | 0.06 | 6 | 5 | 2 | 1.96 | 91.05 | −3.68 | 83.81 | 80.08 |
| SL2 | 0.11 | 7 | 6 | 2 | 2.7 | 97.54 | −3.74 | 93.04 | 76.90 |
| SL3 | 0.05 | 6 | 5 | 2 | 2.61 | 108.55 | −4.81 | 83.81 | 80.08 |
| SL4 | 0.06 | 6 | 5 | 1 | 1.74 | 86.82 | −3.16 | 76.47 | 82.61 |
| [Cu(SL1)2] | 0.06 | 16 | 10 | 2 | 0 | 179.3 | −7.53 | 173.28 | 49.20 |
| [Zn(SL1)2] | 0.06 | 16 | 10 | 2 | 0 | 179.3 | −7.54 | 173.28 | 49.20 |
| [Cu(SL2)2] | 0.11 | 18 | 12 | 2 | 0 | 192.29 | −7.7 | 191.74 | 42.84 |
| [Zn(SL2)2] | 0.11 | 18 | 12 | 2 | 0 | 192.29 | −7.71 | 191.74 | 42.84 |
| [Cu(SL3)2] | 0.05 | 16 | 10 | 2 | 0 | 214.31 | −9.76 | 173.28 | 49.20 |
| [Zn(SL3)2] | 0.05 | 16 | 10 | 2 | 0 | 214.31 | −9.78 | 173.28 | 49.20 |
| [Cu(SL4)2] | 0.06 | 12 | 10 | 2 | 36.16 | 173.64 | −6.35 | 152.94 | 56.23 |
| [Zn(SL4)2] | 0.06 | 12 | 10 | 2 | −45.4 | 173.64 | −6.36 | 152.94 | 56.23 |
- a
The ratio of sp3 hybridized carbons over the total carbon count of the molecule.
- b
Number of hydrogen bond acceptor.
- c
Number of hydrogen bond donor.
- d
Lipophilicity.
- e
Water solubility.
- f
Topological polar surface area (0A2). ESOL = estimated solubility.
3.4.2 In silico pharmacokinetic/ADME and drug-likeness properties
Pharmacokinetics is used to investigate the time course of chemical absorption, distribution, metabolism, and excretion (ADME) and determines the fate of the chemical administered to the living organisms. In this paper, we have performed in silico pharmacokinetic predictions for the prepared four Schiff base ligands (SL1–SL4) and the prepared corresponding Cu(ii) and Zn(ii) metal complexes and the obtained results are presented in Table 7. The gastrointestinal (GI) absorption score measures the extent of absorption of a chemical from the intestine, the results pointed out that all the ligands have high GI absorption and hence had excellent absorption possibility from the intestine after oral administration, while the complexes showed low GI absorption and hence had low absorption possibility from the intestine. It was very interesting that all the ligands and complexes were unable to penetrate through the blood–brain barrier (BBB) except the ligand SL4. Besides this drug-likeness is the other parameter, which gives the probability of the molecules for the drug candidate. In the light of the drug-likeness definition, the chemical has a logarithm of the partition (log P) (i.e., octanol/water partition coefficient used to predict the solubility of a probable oral drug) between −0.4 and 5.6 values [46]. The skin permeability coefficient (Kp) is a criterion that considers the octanol/water partition coefficient to be a direct effect on the transdermal movement of chemical molecules and used to quantitatively describe the potential of dermal absorption for the synthesized compounds. In our study, log Kp values for all examined ligands and complexes were in the range of −7.50 to −5.04, which are below −0.4 indicating low lipophilicity and cannot penetrate through the lipid bilayers of the cells and suggesting that the synthesized compounds have bad drug-likeness. In addition, to discriminate between the drug-like and non-drug-like chemical substances, the Lipinski (rule-of-five) that describes the relationship between pharmacokinetic and physicochemical parameters, Ghose, Veber, Egan, and Muegge rules were applied to predict whether the target compounds are likely to be bioactive and assess qualitatively the chance of these compounds to become oral drug candidates [19]. The number of violations to these rules is listed in Table 8. All the ligands fulfilled Lipinski rule and other rules and showed zero violation against all the rules, while all the complexes showed two violations against the Lipinski rule and different violations against the other rules. All the ligands in the screening processes showed good bioavailability with a score of 0.55, which is an indication that all organic ligands reach the circulation system, whereas the complexes showed moderate to poor bioavailability with scores in the range 0.11–0.17 and hence cannot reach the circulation system easily.
Pharmacokinetic/ADME (absorption, distribution, metabolism, and excretion) properties of the ligands and complex compounds
| Compound no. | Pharmacokinetic/ADME properties | ||||||||
|---|---|---|---|---|---|---|---|---|---|
| GI | BBB | P-gp | CYP1A2 | CYP2C19 | CYP2C9 | CYP2D6 | CYP3A4 | log Kpi | |
| Absa | Permeantb | Substratec | Inhibitord | Inhibitore | Inhibitorf | Inhibitorg | Inhibitorh | ||
| SL1 | High | No | No | Yes | No | Yes | Yes | No | −6.29 |
| SL2 | High | No | No | Yes | No | Yes | Yes | Yes | −6.49 |
| SL3 | High | No | No | Yes | Yes | Yes | Yes | Yes | −5.7 |
| SL4 | High | Yes | No | Yes | Yes | Yes | Yes | No | −6.7 |
| [Cu(SL1)2] | Low | No | No | No | No | Yes | No | Yes | −6.2 |
| [Zn(SL1)2] | Low | No | No | No | No | Yes | No | Yes | −6.21 |
| [Cu(SL2)2] | Low | No | No | No | No | Yes | No | Yes | −6.61 |
| [Zn(SL2)2] | Low | No | No | No | No | Yes | No | Yes | −6.62 |
| [Cu(SL3)2] | Low | No | Yes | No | No | No | No | Yes | −5.04 |
| [Zn(SL3)2] | Low | No | Yes | No | No | No | No | Yes | −5.05 |
| [Cu(SL4)2] | Low | No | Yes | No | No | No | No | No | −7.49 |
| [Zn(SL4)2] | Low | No | Yes | No | No | No | No | No | −7.5 |
- a
Gastro intestinal absorption.
- b
Blood–brain barrier permeant.
- c
P-glycoprotein substrate.
- d
CYP1A2: cytochrome P450 family1 subfamily A member 2(PDBHI4).
- e
CYP2C19: cytochrome P450 family2 subfamily C member 19(PDB4GQS).
- f
CYP2C9: cytochrome P450 family2 subfamily C member 9 (PDB1OG2).
- g
CYP2D6: cytochrome P450 family 2 subfamily D member 6 (PDB5TFT).
- h
CYP3A4: cytochrome P450 family 3 subfamily A member 4 (PDB4K9T).
- i
Skin permeation in cm/s.
Drug likeness predictions of the target compounds
| Compounds no. | Lipinski violations | Ghose violation | Veber violation | Egan violation | Muegge violation | Bioavailability score |
|---|---|---|---|---|---|---|
| SL1 | 0 | 0 | 0 | 0 | 0 | 0.55 |
| SL2 | 0 | 0 | 0 | 0 | 0 | 0.55 |
| SL3 | 0 | 0 | 0 | 0 | 0 | 0.55 |
| SL4 | 0 | 0 | 0 | 0 | 0 | 0.55 |
| [Cu(SL1)2] | 2 | 3 | 2 | 1 | 4 | 0.11 |
| [Zn(SL1)2] | 2 | 3 | 2 | 1 | 4 | 0.11 |
| [Cu(SL2)2] | 2 | 3 | 2 | 1 | 5 | 0.11 |
| [Zn(SL2)2] | 2 | 3 | 2 | 1 | 5 | 0.11 |
| [Cu(SL3)2] | 2 | 4 | 2 | 2 | 5 | 0.11 |
| [Zn(SL3)2] | 2 | 4 | 2 | 2 | 5 | 0.11 |
| [Cu(SL4)2] | 2 | 3 | 2 | 1 | 2 | 0.17 |
| [Zn(SL4)2] | 2 | 3 | 2 | 1 | 2 | 0.17 |
The prediction of the interaction of the tested compounds with cytochromes CYP450 major isoforms (CYP1A2, CYP2C19, CYP2C9, CYP2D6, and CYP3A4) was performed in order to check which compound will cause significant pharmacokinetic interactions that lead to toxic effect through inhibition of these isoenzymes. The CYP450 inhibition prediction results (Table 7) indicated that all synthesized ligands have probable inhibition to the CYP1A2, CYP2C9 and CYP2D6 isoforms. The ligand SL3 showed inhibition possibility for all CYP450 isoforms. The majority of metal complexes showed inhibition possibility to the CYP3A4 isoform and no inhibition to the other CYP450 isoforms. The complexes with SL4 ligand [Cu(SL4)2] and [Zn(SL4)2] showed no inhibition to all isoforms. Moreover, the probability of the compounds to be the substrate of P-glycoprotein (P-gp) was suggesting that ligands and the majority of complexes have a probability to be nonsubstrate of P-gp. The complexes obtained from SL3 and SL4 showed a probability to be the substrate of P-gp. These results suggesting the more favor of non-drug-likeness of the tested compounds.
4 Conclusion
We have successfully prepared four new Schiff base ligands (SL1–SL4) with a quinoline hydrazine scaffold. The prepared Schiff base ligands were characterized, and their structures were proved before proceeding for the next step. A series of Cu(ii) and Zn(ii) complexes were synthesized using these ligands. The chemical and spectroscopic analyses results revealed that the ligands behaved as bidentate ligands and coordinated to the Cu(ii) and Zn(ii) metal ions through the N atom of the azomethine group and the O atom of the phenolic group or the ketonic O atom in case of SL4 ligand and forming square-planar geometry. All the complexes were mononuclear and the general formula for complexes obtained from the ligands was of the type [M(SL1—4)2].
For proving the proposed structures of synthesized ligands and their corresponding metal complexes, we performed elemental analysis and various spectroscopic measurements, which showed similarities with the theoretically expected results indicating the formation of the compounds and proving their structures. Moreover, for metal complexes thermal analysis, magnetic moment and molar conductance measurements were investigated, and the results were in support of the estimated structures. Molar conductance measurement experimentation showed that the metal complexes were nonelectrolytic in nature. All synthesized ligands and complexes were screened for in vitro for testing antibacterial and antifungal activities. The organic ligands (SL1–SL4) exhibited moderate antibacterial activity against the Gram-positive bacterial types with zones of inhibitions in the range of 8–25 mm, which is much less than the standard reference drug. They were inactive against the Gram-negative bacteria and fungus strains and showed no zones of inhibition. The metal complexes showed some enhancement in the activity against the Gram-positive bacterial strains and were inactive against the Gram-negative bacteria and the fungus strains similar to the parent ligands. [Cu(SL1)2] complexes were the most toxic compounds against both Gram-positive S. aureus and E. faecalis bacteria, but still less than the reference drugs.
In silico physicochemical investigation revealed that among the ligands, the ligand SL4 showed highest in silico absorption with 82.61% and [Cu(SL4)2] and [Zn(SL4)2] complexes showed highest in silico absorption percentage of 56.23% among the complexes. The in silico pharmacokinetics predictions showed that the ligands have high GI absorption and the complexes showed low GI absorption. The ligands showed a good bioavailability score of 0.55 where the complexes showed moderate to poor bioavailability.
Finally, we recommend further investigations on the Schiff base ligands containing quinoline moiety and preparation of metal complexes using other metal ions and examining their biological activities. Moreover, other investigations are going on for their applications as catalysts, corrosion inhibitors, using these Schiff base ligands as chemosensors for the detection of heavy metal ions in different sources.
Acknowledgment
The authors are very grateful to the Head of the Chemistry Department and the Dean, Faculty of Science at Albaha University for laboratory facilities and encouragements.
Conflict of interest: The authors declare that no conflict of interest exists.
References
[1] Zabin SA, Abdelbaset M. Oxo/dioxo-vanadium(v) complexes with Schiff base ligands derived from 4-amino-5-mercapto-3-phenyl-1,2,4-triazole. Eur J Chem. 2016;7(3):322–8.10.5155/eurjchem.7.3.322-328.1444Search in Google Scholar
[2] Majid SA, Mir JM, Paul S, Akhter M, Parray H, Ayoub R, et al. Experimental and molecular topology-based biological implications of Schiff base complexes: a concise review. Rev Inorg Chem. 2019;39(2):113–28.10.1515/revic-2018-0023Search in Google Scholar
[3] da Silva CM, da Silva DL, Modolo LV, Alves RB, de Resende MA, Martins CV, et al. Schiff bases: a short review of their antimicrobial activities. J Adv Res. 2011;2(1):1–8.10.1016/j.jare.2010.05.004Search in Google Scholar
[4] Chaturvedi D, Kamboj M. Role of Schiff base in drug discovery research. Chem Sci J. 2016;7(2):e114.10.4172/2150-3494.1000e114Search in Google Scholar
[5] Mallandur BK, Rangaiah G, Harohally NV. Synthesis and antimicrobial activity of Schiff bases derived from 2-chloro quinoline-3-carbaldehyde and its derivatives incorporating 7-methyl-2-propyl-3H-benzoimidazole-5-carboxylic acid hydrazide. Synth Commun. 2017;47(11):1065–70.10.1080/00397911.2017.1309668Search in Google Scholar
[6] Yernale NG, Mathada MBH. Synthesis, characterization, antimicrobial, DNA cleavage, and in vitro cytotoxic studies of some metal complexes of Schiff base ligand derived from thiazole and quinoline moiety. Bioinorg Chem Appl. 2014;2014:314963.Search in Google Scholar
[7] Mistry BM, Kim DH, Jauhari S. Analysis of adsorption properties and corrosion inhibition of mild steel in hydrochloric acid solution by synthesized quinoline Schiff base derivatives. Trans Indian Inst Met. 2016;69(6):1297–309.10.1007/s12666-015-0690-xSearch in Google Scholar
[8] Salve PS, Alegaon SG, Srirram D. Three-component, one-pot synthesis of anthranilamide Schiff bases bearing 4-aminoquinoline moiety as Mycobacterium tuberculosis gyrase inhibitors. Bioorg Med Chem Lett. 2017;27:1859–66.10.1016/j.bmcl.2017.02.031Search in Google Scholar PubMed
[9] Mandewale MC, Thorat B, Nivid Y, Jadhav R, Nagarsekar A, Yamgar R. Synthesis, structural studies and antituberculosis evaluation of new hydrazone derivatives of quinoline and their Zn(ii) complexes. J Saudi Chem Soc. 2018;22:218–28.10.1016/j.jscs.2016.04.003Search in Google Scholar
[10] Patil DY, Patil AA, Khadke NB, Borhade AV. Highly selective and sensitive colorimetric probe for Al3+ and Fe3+ metal ions based on 2-aminoquinolin-3-yl phenyl hydrazone Schiff base. Inorg Chim Acta. 2019;492:167–76.10.1016/j.ica.2019.04.006Search in Google Scholar
[11] Hayat F, Salahuddin A, Umar S, Azam A. Synthesis, characterization, antiamoebic activity and cytotoxicity of novel series of pyrazoline derivatives bearing quinoline tail. Eur J Med Chem. 2010;45(10):4669–75.10.1016/j.ejmech.2010.07.028Search in Google Scholar PubMed
[12] Boukabcha N, Djafri A, Megrouss Y, Tamer O, Avci D, Tuna M, et al. Synthesis, crystal structure, spectroscopic characterization and nonlinear optical properties of (Z)-N′-(2,4-dinitrobenzylidene)-2-(quinolin-8-yloxy)acetohydrazide. J Mol Struct. 2019;1194:112–23.10.1016/j.molstruc.2019.05.074Search in Google Scholar
[13] Ahmed M, Sharma R, Nagda DP, Jat JL, Talesara GL. Synthesis and antimicrobial activity of succinimido(2-aryl-4-oxo-3-{[(quinolin-8-yloxy)acetyl]amino}-1,3-thiazolidin-5-yl)acetates. ARKIVOC. 2006;11:66–75.10.3998/ark.5550190.0007.b06Search in Google Scholar
[14] Kavitha P, Saritha M, Reddy KL. Synthesis, structural characterization, fluorescence, antimicrobial, antioxidant and DNA cleavage studies of Cu(ii) complexes of formyl chromone Schiff bases. Spectrochim Acta A Mol Biomol Spectrosc. 2013;102:159–68.10.1016/j.saa.2012.10.037Search in Google Scholar PubMed
[15] Zabin SA. Antimicrobial, antiradical capacity and chemical analysis of Conyza incana essential oil extracted from aerial parts. J Essent Oil Bear Pl. 2018;21(2):502–10.10.1080/0972060X.2018.1465362Search in Google Scholar
[16] Anand SAA, Loganathan C, Saravanan K, Alphonsa AJ, Kabilan S, Thomas NS. Synthesis, structure prediction, pharmacokinetic properties, molecular docking and antitumor activities of some novel thiazinone derivatives. N J Chem. 2015;39(9):7120–9.10.1039/C5NJ01369KSearch in Google Scholar
[17] Feng X-Y, Jia W-Q, Liu X, Jing Z, Liu Y-Y, Xu W-R, et al. Identification of novel PPARα/γ dual agonists by pharmacophore screening, docking analysis, ADMET prediction and molecular dynamics simulations. Comput Biol Chem. 2019;78:178–89.10.1016/j.compbiolchem.2018.11.023Search in Google Scholar PubMed
[18] Daina A, Michielin O, Zoete V. Swiss target prediction: updated data and new features for efficient prediction of protein targets of small molecules. Nucl Acids Res. 2019;47(W1):W357–64.10.1093/nar/gkz382Search in Google Scholar PubMed PubMed Central
[19] Raj S, Sasidharan S, Dubey VK, Saudagar P. Identification of lead molecules against potential drug target protein MAPK4 from L. donovani: an in silico approach using docking, molecular dynamics and binding free energy calculation. PLoS One. 2019;14(8):e0221331.10.1371/journal.pone.0221331Search in Google Scholar PubMed PubMed Central
[20] Zabin SA. Cu(ii) and Ni(ii) complexes derived from tridentate ligands with N═N and CH═N linkages: characterization and antimicrobial activity. Albaha Univ J Basic Appl Sci. 2017;1(2):9–18.Search in Google Scholar
[21] Mandewale MC, Thorat B, Shelke D, Yamgar R. Synthesis and biological evaluation of new hydrazone derivatives of quinoline and their Cu(ii) and Zn(ii) complexes against Mycobacterium tuberculosis. Bioinorg Chem Appl. 2015;2015:153015.10.1155/2015/153015Search in Google Scholar PubMed PubMed Central
[22] Saghatforoush LA, Chalabian F, Aminkhani A, Karimnezhad G, Ershad S. Synthesis, spectroscopic characterization and antibacterial activity of new cobalt(ii) complexes of unsymmetrical tetradentate (OSN2) Schiff base ligands. Eur J Med Chem. 2009;44:4490–5.10.1016/j.ejmech.2009.06.015Search in Google Scholar PubMed
[23] Bharadwaj SS, Poojary B, Kumar SM, Byrappa K, Nagananda GS, Chaitanya AK, et al. Design, synthesis and pharmacological studies of some new quinoline Schiff bases and 2,5-(disubstituted-[1,3,4])-oxadiazoles. N J Chem. 2017;41(16):8568–85.10.1039/C6NJ03913HSearch in Google Scholar
[24] Paciorek P, Szklarzewicz J, Jasinska A, Trzewik B, Nitek W, Hodorowicz M. Synthesis, structural characterization and spectroscopy studies of new oxovanadium(iv,v) complexes with hydrazone ligands. Polyhedron. 2015;87:226–32.10.1016/j.poly.2014.11.018Search in Google Scholar
[25] Al-Shaalan NH. Synthesis, characterization and biological activities of Cu(ii), Co(ii), Mn(ii), Fe(ii), and UO2(vi) complexes with a new Schiff base hydrazone: o-hydroxyacetophenone-7-chloro-4-quinoline hydrazine. Molecules. 2011;16:8629–45.10.3390/molecules16108629Search in Google Scholar PubMed PubMed Central
[26] Rudbari HA, Iravani MR, Moazam V, Askari B, Khorshidifard M, Habibi N, et al. Synthesis, characterization, X-ray crystal structures and antibacterial activities of Schiff base ligands derived from allylamine and their vanadium(iv), cobalt(iii), nickel(ii), copper(ii), zinc(ii) and palladium(ii) complexes. J Mol Struct. 2016;1125:113–20.10.1016/j.molstruc.2016.06.055Search in Google Scholar
[27] Orojloo M, Zolgharnein P, Solimannejad M, Amani S. Synthesis and characterization of cobalt(ii), nickel(ii), copper(ii) and zinc(ii) complexes derived from two Schiff base ligands: spectroscopic, thermal, magnetic moment, electrochemical and antimicrobial studies. Inorg Chim Acta. 2017;467:227–37.10.1016/j.ica.2017.08.016Search in Google Scholar
[28] Gup R, Kirkan B. Synthesis and spectroscopic studies of mixed-ligand and polymeric dinuclear transition metal complexes with bis-acylhydrazone tetradentate ligands and 1,10-phenanthroline. Spectrochim Acta A Mol Biomol Spectrosc. 2006;64:809–15.10.1016/j.saa.2005.08.008Search in Google Scholar PubMed
[29] Shaghaghi Z. Spectroscopic properties of some new azo–azomethine ligands in the presence of Cu2+, Pb2+, Hg2+, Co2+, Ni2+, Cd2+ and Zn2+ and their antioxidant activity. Spectrochim Acta A Mol Biomol Spectrosc. 2014;131:67–71.10.1016/j.saa.2014.04.026Search in Google Scholar PubMed
[30] More G, Raut D, Aruna K, Bootwala S. Synthesis, spectroscopic characterization and antimicrobial activity evaluation of new tridentate Schiff bases and their Co(ii) complexes. J Saudi Chem Soc. 2017;21:954–64.10.1016/j.jscs.2017.05.002Search in Google Scholar
[31] Alaghaz AMA, Ammar YA, Bayoumi HA, Aldhlmani SA. Synthesis, spectral characterization, thermal analysis, molecular modeling and antimicrobial activity of new potentially N2O2 azo-dye Schiff base complexes. J Mol Struct. 2014;1074:359–75.10.1016/j.molstruc.2014.05.078Search in Google Scholar
[32] Mahal A, Abu-El-Halawa R, Zabin SA, Ibrahim M, Al-Refai M. Synthesis, characterization and antifungal activity of some metal complexes derived from quinoxaloylhydrazone. World J Org Chem. 2015;3(1):1–8.Search in Google Scholar
[33] Shakdofa MME, El‐Saied FA, Rasras AJ, Al‐Hakimi AN. Transition metal complexes of a hydrazone–oxime ligand containing the isonicotinoyl moiety: Synthesis, characterization and microbicide activities. Appl Organomet Chem. 2018;32(7):e4376.10.1002/aoc.4376Search in Google Scholar
[34] Ejidike IP, Ajibade PA. Synthesis, characterization, anticancer, and antioxidant studies of Ru(iii) complexes of monobasic tridentate Schiff bases. Bioinorg Chem Appl. 2016;2016:9672451.10.1155/2016/9672451Search in Google Scholar
[35] Salehi M, Rahimifar F, Kubicki M, Asadi A. Structural, spectroscopic, electrochemical and antibacterial studies of some new nickel(ii) Schiff base complexes. Inorg Chim Acta. 2016;443:28–35.10.1016/j.ica.2015.12.016Search in Google Scholar
[36] Sonmez M. Synthesis and characterization of copper(ii), nickel(ii), cadmium(ii), cobalt(ii) and zinc(ii) complexes with 2-benzoyl-3-hydroxy-1-naphthylamino-3-phenyl-2-propen-1-on. Turk J Chem. 2011;25:181–5.Search in Google Scholar
[37] Das M, Chattopadhyay S. Designed synthesis of copper(ii) and nickel(ii) complexes with a tridentate N2O donor Schiff base: Modulation of crystalline architectures through C–H⋯π and anion⋯π interactions. J Mol Struct. 2013;1051:250–8.10.1016/j.molstruc.2013.07.045Search in Google Scholar
[38] Chah CK, Ravoof TBSA, Veerakumarasivam A. Synthesis, characterization and biological activities of Ru(iii), Mo(v), Cd(ii), Zn(ii) and Cu(ii) complexes containing a novel nitrogen-sulphur macrocyclic Schiff base derived from glyoxal. Pertanika J Sci Technol. 2018;26(2):653–70.Search in Google Scholar
[39] Mahmoud WH, Mohamed GG, Elsawy HA, Mostafa A, Radwan MA. Metal complexes of novel Schiff base derived from the condensation of 2‐quinoline carboxaldehyde and ambroxol drug with some transition metal ions. Appl Organomet Chem. 2018;32(7):e4392.10.1002/aoc.4392Search in Google Scholar
[40] Fonkui TY, Ikhile MI, Ndinteh DT, Njobeh PB. Microbial activity of some heterocyclic Schiff bases and metal complexes: a review. Trop J Pharm Res. 2018;17(12):2507–18.10.4314/tjpr.v17i12.29Search in Google Scholar
[41] Alias M, Kassum H, Shakir C. Synthesis, physical characterization and biological evaluation of Schiff base M(ii) complexes. J Assoc Arab Univ Basic Appl Sci. 2014;15:28–34.10.1016/j.jaubas.2013.03.001Search in Google Scholar
[42] El-Sherif AA, Shoukry MM, Abd-Elgawad MMA. Synthesis, characterization, biological activity and equilibrium studies of metal(ii) ion complexes with tridentate hydrazone ligand derived from hydralazine. Spectrochim Acta A Mol Biomol Spectrosc. 2012;98:307–21.10.1016/j.saa.2012.08.034Search in Google Scholar
[43] Kramer SD, Wunderli-Allenspach H. Physicochemical properties in pharmacokinetic lead optimization. Farmaco. 2001;56(1–2):145–8.10.1016/S0014-827X(01)01028-XSearch in Google Scholar
[44] Neervannan S. Preclinical formulations for discovery and toxicology: Physicochemical challenges. Expert Opin Drug Metab Toxicol. 2006;2(5):715–31.10.1517/17425255.2.5.715Search in Google Scholar PubMed
[45] Souza HDS, de Sousa PF, Lira BF, et al. Synthesis, in silico study and antimicrobial evaluation of new selenoglycolicamides. J Braz Chem Soc. 2019;30(1):188–97.10.21577/0103-5053.20180148Search in Google Scholar
[46] Ghose AK, Viswanadhan VN, Wendoloski JJ. A knowledge-based approach in designing combinatorial or medicinal chemistry libraries for drug discovery. 1. A qualitative and quantitative characterization of known drug databases. J Comb Chem. 1999;1(1):55–68.10.1021/cc9800071Search in Google Scholar PubMed
© 2020 Hanan A. Althobiti and Sami A. Zabin, published by De Gruyter
This work is licensed under the Creative Commons Attribution 4.0 International License.
Articles in the same Issue
- Regular Articles
- Electrochemical antioxidant screening and evaluation based on guanine and chitosan immobilized MoS2 nanosheet modified glassy carbon electrode (guanine/CS/MoS2/GCE)
- Kinetic models of the extraction of vanillic acid from pumpkin seeds
- On the maximum ABC index of bipartite graphs without pendent vertices
- Estimation of the total antioxidant potential in the meat samples using thin-layer chromatography
- Molecular dynamics simulation of sI methane hydrate under compression and tension
- Spatial distribution and potential ecological risk assessment of some trace elements in sediments and grey mangrove (Avicennia marina) along the Arabian Gulf coast, Saudi Arabia
- Amino-functionalized graphene oxide for Cr(VI), Cu(II), Pb(II) and Cd(II) removal from industrial wastewater
- Chemical composition and in vitro activity of Origanum vulgare L., Satureja hortensis L., Thymus serpyllum L. and Thymus vulgaris L. essential oils towards oral isolates of Candida albicans and Candida glabrata
- Effect of excess Fluoride consumption on Urine-Serum Fluorides, Dental state and Thyroid Hormones among children in “Talab Sarai” Punjab Pakistan
- Design, Synthesis and Characterization of Novel Isoxazole Tagged Indole Hybrid Compounds
- Comparison of kinetic and enzymatic properties of intracellular phosphoserine aminotransferases from alkaliphilic and neutralophilic bacteria
- Green Organic Solvent-Free Oxidation of Alkylarenes with tert-Butyl Hydroperoxide Catalyzed by Water-Soluble Copper Complex
- Ducrosia ismaelis Asch. essential oil: chemical composition profile and anticancer, antimicrobial and antioxidant potential assessment
- DFT calculations as an efficient tool for prediction of Raman and infra-red spectra and activities of newly synthesized cathinones
- Influence of Chemical Osmosis on Solute Transport and Fluid Velocity in Clay Soils
- A New fatty acid and some triterpenoids from propolis of Nkambe (North-West Region, Cameroon) and evaluation of the antiradical scavenging activity of their extracts
- Antiplasmodial Activity of Stigmastane Steroids from Dryobalanops oblongifolia Stem Bark
- Rapid identification of direct-acting pancreatic protectants from Cyclocarya paliurus leaves tea by the method of serum pharmacochemistry combined with target cell extraction
- Immobilization of Pseudomonas aeruginosa static biomass on eggshell powder for on-line preconcentration and determination of Cr (VI)
- Assessment of methyl 2-({[(4,6-dimethoxypyrimidin-2-yl)carbamoyl] sulfamoyl}methyl)benzoate through biotic and abiotic degradation modes
- Stability of natural polyphenol fisetin in eye drops Stability of fisetin in eye drops
- Production of a bioflocculant by using activated sludge and its application in Pb(II) removal from aqueous solution
- Molecular Properties of Carbon Crystal Cubic Structures
- Synthesis and characterization of calcium carbonate whisker from yellow phosphorus slag
- Study on the interaction between catechin and cholesterol by the density functional theory
- Analysis of some pharmaceuticals in the presence of their synthetic impurities by applying hybrid micelle liquid chromatography
- Two mixed-ligand coordination polymers based on 2,5-thiophenedicarboxylic acid and flexible N-donor ligands: the protective effect on periodontitis via reducing the release of IL-1β and TNF-α
- Incorporation of silver stearate nanoparticles in methacrylate polymeric monoliths for hemeprotein isolation
- Development of ultrasound-assisted dispersive solid-phase microextraction based on mesoporous carbon coated with silica@iron oxide nanocomposite for preconcentration of Te and Tl in natural water systems
- N,N′-Bis[2-hydroxynaphthylidene]/[2-methoxybenzylidene]amino]oxamides and their divalent manganese complexes: Isolation, spectral characterization, morphology, antibacterial and cytotoxicity against leukemia cells
- Determination of the content of selected trace elements in Polish commercial fruit juices and health risk assessment
- Diorganotin(iv) benzyldithiocarbamate complexes: synthesis, characterization, and thermal and cytotoxicity study
- Keratin 17 is induced in prurigo nodularis lesions
- Anticancer, antioxidant, and acute toxicity studies of a Saudi polyherbal formulation, PHF5
- LaCoO3 perovskite-type catalysts in syngas conversion
- Comparative studies of two vegetal extracts from Stokesia laevis and Geranium pratense: polyphenol profile, cytotoxic effect and antiproliferative activity
- Fragmentation pattern of certain isatin–indole antiproliferative conjugates with application to identify their in vitro metabolic profiles in rat liver microsomes by liquid chromatography tandem mass spectrometry
- Investigation of polyphenol profile, antioxidant activity and hepatoprotective potential of Aconogonon alpinum (All.) Schur roots
- Lead discovery of a guanidinyl tryptophan derivative on amyloid cascade inhibition
- Physicochemical evaluation of the fruit pulp of Opuntia spp growing in the Mediterranean area under hard climate conditions
- Electronic structural properties of amino/hydroxyl functionalized imidazolium-based bromide ionic liquids
- New Schiff bases of 2-(quinolin-8-yloxy)acetohydrazide and their Cu(ii), and Zn(ii) metal complexes: their in vitro antimicrobial potentials and in silico physicochemical and pharmacokinetics properties
- Treatment of adhesions after Achilles tendon injury using focused ultrasound with targeted bFGF plasmid-loaded cationic microbubbles
- Synthesis of orotic acid derivatives and their effects on stem cell proliferation
- Chirality of β2-agonists. An overview of pharmacological activity, stereoselective analysis, and synthesis
- Fe3O4@urea/HITh-SO3H as an efficient and reusable catalyst for the solvent-free synthesis of 7-aryl-8H-benzo[h]indeno[1,2-b]quinoline-8-one and indeno[2′,1′:5,6]pyrido[2,3-d]pyrimidine derivatives
- Adsorption kinetic characteristics of molybdenum in yellow-brown soil in response to pH and phosphate
- Enhancement of thermal properties of bio-based microcapsules intended for textile applications
- Exploring the effect of khat (Catha edulis) chewing on the pharmacokinetics of the antiplatelet drug clopidogrel in rats using the newly developed LC-MS/MS technique
- A green strategy for obtaining anthraquinones from Rheum tanguticum by subcritical water
- Cadmium (Cd) chloride affects the nutrient uptake and Cd-resistant bacterium reduces the adsorption of Cd in muskmelon plants
- Removal of H2S by vermicompost biofilter and analysis on bacterial community
- Structural cytotoxicity relationship of 2-phenoxy(thiomethyl)pyridotriazolopyrimidines: Quantum chemical calculations and statistical analysis
- A self-breaking supramolecular plugging system as lost circulation material in oilfield
- Synthesis, characterization, and pharmacological evaluation of thiourea derivatives
- Application of drug–metal ion interaction principle in conductometric determination of imatinib, sorafenib, gefitinib and bosutinib
- Synthesis and characterization of a novel chitosan-grafted-polyorthoethylaniline biocomposite and utilization for dye removal from water
- Optimisation of urine sample preparation for shotgun proteomics
- DFT investigations on arylsulphonyl pyrazole derivatives as potential ligands of selected kinases
- Treatment of Parkinson’s disease using focused ultrasound with GDNF retrovirus-loaded microbubbles to open the blood–brain barrier
- New derivatives of a natural nordentatin
- Fluorescence biomarkers of malignant melanoma detectable in urine
- Study of the remediation effects of passivation materials on Pb-contaminated soil
- Saliva proteomic analysis reveals possible biomarkers of renal cell carcinoma
- Withania frutescens: Chemical characterization, analgesic, anti-inflammatory, and healing activities
- Design, synthesis and pharmacological profile of (−)-verbenone hydrazones
- Synthesis of magnesium carbonate hydrate from natural talc
- Stability-indicating HPLC-DAD assay for simultaneous quantification of hydrocortisone 21 acetate, dexamethasone, and fluocinolone acetonide in cosmetics
- A novel lactose biosensor based on electrochemically synthesized 3,4-ethylenedioxythiophene/thiophene (EDOT/Th) copolymer
- Citrullus colocynthis (L.) Schrad: Chemical characterization, scavenging and cytotoxic activities
- Development and validation of a high performance liquid chromatography/diode array detection method for estrogen determination: Application to residual analysis in meat products
- PCSK9 concentrations in different stages of subclinical atherosclerosis and their relationship with inflammation
- Development of trace analysis for alkyl methanesulfonates in the delgocitinib drug substance using GC-FID and liquid–liquid extraction with ionic liquid
- Electrochemical evaluation of the antioxidant capacity of natural compounds on glassy carbon electrode modified with guanine-, polythionine-, and nitrogen-doped graphene
- A Dy(iii)–organic framework as a fluorescent probe for highly selective detection of picric acid and treatment activity on human lung cancer cells
- A Zn(ii)–organic cage with semirigid ligand for solvent-free cyanosilylation and inhibitory effect on ovarian cancer cell migration and invasion ability via regulating mi-RNA16 expression
- Polyphenol content and antioxidant activities of Prunus padus L. and Prunus serotina L. leaves: Electrochemical and spectrophotometric approach and their antimicrobial properties
- The combined use of GC, PDSC and FT-IR techniques to characterize fat extracted from commercial complete dry pet food for adult cats
- MALDI-TOF MS profiling in the discovery and identification of salivary proteomic patterns of temporomandibular joint disorders
- Concentrations of dioxins, furans and dioxin-like PCBs in natural animal feed additives
- Structure and some physicochemical and functional properties of water treated under ammonia with low-temperature low-pressure glow plasma of low frequency
- Mesoscale nanoparticles encapsulated with emodin for targeting antifibrosis in animal models
- Amine-functionalized magnetic activated carbon as an adsorbent for preconcentration and determination of acidic drugs in environmental water samples using HPLC-DAD
- Antioxidant activity as a response to cadmium pollution in three durum wheat genotypes differing in salt-tolerance
- A promising naphthoquinone [8-hydroxy-2-(2-thienylcarbonyl)naphtho[2,3-b]thiophene-4,9-dione] exerts anti-colorectal cancer activity through ferroptosis and inhibition of MAPK signaling pathway based on RNA sequencing
- Synthesis and efficacy of herbicidal ionic liquids with chlorsulfuron as the anion
- Effect of isovalent substitution on the crystal structure and properties of two-slab indates BaLa2−xSmxIn2O7
- Synthesis, spectral and thermo-kinetics explorations of Schiff-base derived metal complexes
- An improved reduction method for phase stability testing in the single-phase region
- Comparative analysis of chemical composition of some commercially important fishes with an emphasis on various Malaysian diets
- Development of a solventless stir bar sorptive extraction/thermal desorption large volume injection capillary gas chromatographic-mass spectrometric method for ultra-trace determination of pyrethroids pesticides in river and tap water samples
- A turbidity sensor development based on NL-PI observers: Experimental application to the control of a Sinaloa’s River Spirulina maxima cultivation
- Deep desulfurization of sintering flue gas in iron and steel works based on low-temperature oxidation
- Investigations of metallic elements and phenolics in Chinese medicinal plants
- Influence of site-classification approach on geochemical background values
- Effects of ageing on the surface characteristics and Cu(ii) adsorption behaviour of rice husk biochar in soil
- Adsorption and sugarcane-bagasse-derived activated carbon-based mitigation of 1-[2-(2-chloroethoxy)phenyl]sulfonyl-3-(4-methoxy-6-methyl-1,3,5-triazin-2-yl) urea-contaminated soils
- Antimicrobial and antifungal activities of bifunctional cooper(ii) complexes with non-steroidal anti-inflammatory drugs, flufenamic, mefenamic and tolfenamic acids and 1,10-phenanthroline
- Application of selenium and silicon to alleviate short-term drought stress in French marigold (Tagetes patula L.) as a model plant species
- Screening and analysis of xanthine oxidase inhibitors in jute leaves and their protective effects against hydrogen peroxide-induced oxidative stress in cells
- Synthesis and physicochemical studies of a series of mixed-ligand transition metal complexes and their molecular docking investigations against Coronavirus main protease
- A study of in vitro metabolism and cytotoxicity of mephedrone and methoxetamine in human and pig liver models using GC/MS and LC/MS analyses
- A new phenyl alkyl ester and a new combretin triterpene derivative from Combretum fragrans F. Hoffm (Combretaceae) and antiproliferative activity
- Erratum
- Erratum to: A one-step incubation ELISA kit for rapid determination of dibutyl phthalate in water, beverage and liquor
- Review Articles
- Sinoporphyrin sodium, a novel sensitizer for photodynamic and sonodynamic therapy
- Natural products isolated from Casimiroa
- Plant description, phytochemical constituents and bioactivities of Syzygium genus: A review
- Evaluation of elastomeric heat shielding materials as insulators for solid propellant rocket motors: A short review
- Special Issue on Applied Biochemistry and Biotechnology 2019
- An overview of Monascus fermentation processes for monacolin K production
- Study on online soft sensor method of total sugar content in chlorotetracycline fermentation tank
- Studies on the Anti-Gouty Arthritis and Anti-hyperuricemia Properties of Astilbin in Animal Models
- Effects of organic fertilizer on water use, photosynthetic characteristics, and fruit quality of pear jujube in northern Shaanxi
- Characteristics of the root exudate release system of typical plants in plateau lakeside wetland under phosphorus stress conditions
- Characterization of soil water by the means of hydrogen and oxygen isotope ratio at dry-wet season under different soil layers in the dry-hot valley of Jinsha River
- Composition and diurnal variation of floral scent emission in Rosa rugosa Thunb. and Tulipa gesneriana L.
- Preparation of a novel ginkgolide B niosomal composite drug
- The degradation, biodegradability and toxicity evaluation of sulfamethazine antibiotics by gamma radiation
- Special issue on Monitoring, Risk Assessment and Sustainable Management for the Exposure to Environmental Toxins
- Insight into the cadmium and zinc binding potential of humic acids derived from composts by EEM spectra combined with PARAFAC analysis
- Source apportionment of soil contamination based on multivariate receptor and robust geostatistics in a typical rural–urban area, Wuhan city, middle China
- Special Issue on 13th JCC 2018
- The Role of H2C2O4 and Na2CO3 as Precipitating Agents on The Physichochemical Properties and Photocatalytic Activity of Bismuth Oxide
- Preparation of magnetite-silica–cetyltrimethylammonium for phenol removal based on adsolubilization
- Topical Issue on Agriculture
- Size-dependent growth kinetics of struvite crystals in wastewater with calcium ions
- The effect of silica-calcite sedimentary rock contained in the chicken broiler diet on the overall quality of chicken muscles
- Physicochemical properties of selected herbicidal products containing nicosulfuron as an active ingredient
- Lycopene in tomatoes and tomato products
- Fluorescence in the assessment of the share of a key component in the mixing of feed
- Sulfur application alleviates chromium stress in maize and wheat
- Effectiveness of removal of sulphur compounds from the air after 3 years of biofiltration with a mixture of compost soil, peat, coconut fibre and oak bark
- Special Issue on the 4th Green Chemistry 2018
- Study and fire test of banana fibre reinforced composites with flame retardance properties
- Special Issue on the International conference CosCI 2018
- Disintegration, In vitro Dissolution, and Drug Release Kinetics Profiles of k-Carrageenan-based Nutraceutical Hard-shell Capsules Containing Salicylamide
- Synthesis of amorphous aluminosilicate from impure Indonesian kaolin
- Special Issue on the International Conf on Science, Applied Science, Teaching and Education 2019
- Functionalization of Congo red dye as a light harvester on solar cell
- The effect of nitrite food preservatives added to se’i meat on the expression of wild-type p53 protein
- Biocompatibility and osteoconductivity of scaffold porous composite collagen–hydroxyapatite based coral for bone regeneration
- Special Issue on the Joint Science Congress of Materials and Polymers (ISCMP 2019)
- Effect of natural boron mineral use on the essential oil ratio and components of Musk Sage (Salvia sclarea L.)
- A theoretical and experimental study of the adsorptive removal of hexavalent chromium ions using graphene oxide as an adsorbent
- A study on the bacterial adhesion of Streptococcus mutans in various dental ceramics: In vitro study
- Corrosion study of copper in aqueous sulfuric acid solution in the presence of (2E,5E)-2,5-dibenzylidenecyclopentanone and (2E,5E)-bis[(4-dimethylamino)benzylidene]cyclopentanone: Experimental and theoretical study
- Special Issue on Chemistry Today for Tomorrow 2019
- Diabetes mellitus type 2: Exploratory data analysis based on clinical reading
- Multivariate analysis for the classification of copper–lead and copper–zinc glasses
- Special Issue on Advances in Chemistry and Polymers
- The spatial and temporal distribution of cationic and anionic radicals in early embryo implantation
- Special Issue on 3rd IC3PE 2020
- Magnetic iron oxide/clay nanocomposites for adsorption and catalytic oxidation in water treatment applications
- Special Issue on IC3PE 2018/2019 Conference
- Exergy analysis of conventional and hydrothermal liquefaction–esterification processes of microalgae for biodiesel production
- Advancing biodiesel production from microalgae Spirulina sp. by a simultaneous extraction–transesterification process using palm oil as a co-solvent of methanol
- Topical Issue on Applications of Mathematics in Chemistry
- Omega and the related counting polynomials of some chemical structures
- M-polynomial and topological indices of zigzag edge coronoid fused by starphene
Articles in the same Issue
- Regular Articles
- Electrochemical antioxidant screening and evaluation based on guanine and chitosan immobilized MoS2 nanosheet modified glassy carbon electrode (guanine/CS/MoS2/GCE)
- Kinetic models of the extraction of vanillic acid from pumpkin seeds
- On the maximum ABC index of bipartite graphs without pendent vertices
- Estimation of the total antioxidant potential in the meat samples using thin-layer chromatography
- Molecular dynamics simulation of sI methane hydrate under compression and tension
- Spatial distribution and potential ecological risk assessment of some trace elements in sediments and grey mangrove (Avicennia marina) along the Arabian Gulf coast, Saudi Arabia
- Amino-functionalized graphene oxide for Cr(VI), Cu(II), Pb(II) and Cd(II) removal from industrial wastewater
- Chemical composition and in vitro activity of Origanum vulgare L., Satureja hortensis L., Thymus serpyllum L. and Thymus vulgaris L. essential oils towards oral isolates of Candida albicans and Candida glabrata
- Effect of excess Fluoride consumption on Urine-Serum Fluorides, Dental state and Thyroid Hormones among children in “Talab Sarai” Punjab Pakistan
- Design, Synthesis and Characterization of Novel Isoxazole Tagged Indole Hybrid Compounds
- Comparison of kinetic and enzymatic properties of intracellular phosphoserine aminotransferases from alkaliphilic and neutralophilic bacteria
- Green Organic Solvent-Free Oxidation of Alkylarenes with tert-Butyl Hydroperoxide Catalyzed by Water-Soluble Copper Complex
- Ducrosia ismaelis Asch. essential oil: chemical composition profile and anticancer, antimicrobial and antioxidant potential assessment
- DFT calculations as an efficient tool for prediction of Raman and infra-red spectra and activities of newly synthesized cathinones
- Influence of Chemical Osmosis on Solute Transport and Fluid Velocity in Clay Soils
- A New fatty acid and some triterpenoids from propolis of Nkambe (North-West Region, Cameroon) and evaluation of the antiradical scavenging activity of their extracts
- Antiplasmodial Activity of Stigmastane Steroids from Dryobalanops oblongifolia Stem Bark
- Rapid identification of direct-acting pancreatic protectants from Cyclocarya paliurus leaves tea by the method of serum pharmacochemistry combined with target cell extraction
- Immobilization of Pseudomonas aeruginosa static biomass on eggshell powder for on-line preconcentration and determination of Cr (VI)
- Assessment of methyl 2-({[(4,6-dimethoxypyrimidin-2-yl)carbamoyl] sulfamoyl}methyl)benzoate through biotic and abiotic degradation modes
- Stability of natural polyphenol fisetin in eye drops Stability of fisetin in eye drops
- Production of a bioflocculant by using activated sludge and its application in Pb(II) removal from aqueous solution
- Molecular Properties of Carbon Crystal Cubic Structures
- Synthesis and characterization of calcium carbonate whisker from yellow phosphorus slag
- Study on the interaction between catechin and cholesterol by the density functional theory
- Analysis of some pharmaceuticals in the presence of their synthetic impurities by applying hybrid micelle liquid chromatography
- Two mixed-ligand coordination polymers based on 2,5-thiophenedicarboxylic acid and flexible N-donor ligands: the protective effect on periodontitis via reducing the release of IL-1β and TNF-α
- Incorporation of silver stearate nanoparticles in methacrylate polymeric monoliths for hemeprotein isolation
- Development of ultrasound-assisted dispersive solid-phase microextraction based on mesoporous carbon coated with silica@iron oxide nanocomposite for preconcentration of Te and Tl in natural water systems
- N,N′-Bis[2-hydroxynaphthylidene]/[2-methoxybenzylidene]amino]oxamides and their divalent manganese complexes: Isolation, spectral characterization, morphology, antibacterial and cytotoxicity against leukemia cells
- Determination of the content of selected trace elements in Polish commercial fruit juices and health risk assessment
- Diorganotin(iv) benzyldithiocarbamate complexes: synthesis, characterization, and thermal and cytotoxicity study
- Keratin 17 is induced in prurigo nodularis lesions
- Anticancer, antioxidant, and acute toxicity studies of a Saudi polyherbal formulation, PHF5
- LaCoO3 perovskite-type catalysts in syngas conversion
- Comparative studies of two vegetal extracts from Stokesia laevis and Geranium pratense: polyphenol profile, cytotoxic effect and antiproliferative activity
- Fragmentation pattern of certain isatin–indole antiproliferative conjugates with application to identify their in vitro metabolic profiles in rat liver microsomes by liquid chromatography tandem mass spectrometry
- Investigation of polyphenol profile, antioxidant activity and hepatoprotective potential of Aconogonon alpinum (All.) Schur roots
- Lead discovery of a guanidinyl tryptophan derivative on amyloid cascade inhibition
- Physicochemical evaluation of the fruit pulp of Opuntia spp growing in the Mediterranean area under hard climate conditions
- Electronic structural properties of amino/hydroxyl functionalized imidazolium-based bromide ionic liquids
- New Schiff bases of 2-(quinolin-8-yloxy)acetohydrazide and their Cu(ii), and Zn(ii) metal complexes: their in vitro antimicrobial potentials and in silico physicochemical and pharmacokinetics properties
- Treatment of adhesions after Achilles tendon injury using focused ultrasound with targeted bFGF plasmid-loaded cationic microbubbles
- Synthesis of orotic acid derivatives and their effects on stem cell proliferation
- Chirality of β2-agonists. An overview of pharmacological activity, stereoselective analysis, and synthesis
- Fe3O4@urea/HITh-SO3H as an efficient and reusable catalyst for the solvent-free synthesis of 7-aryl-8H-benzo[h]indeno[1,2-b]quinoline-8-one and indeno[2′,1′:5,6]pyrido[2,3-d]pyrimidine derivatives
- Adsorption kinetic characteristics of molybdenum in yellow-brown soil in response to pH and phosphate
- Enhancement of thermal properties of bio-based microcapsules intended for textile applications
- Exploring the effect of khat (Catha edulis) chewing on the pharmacokinetics of the antiplatelet drug clopidogrel in rats using the newly developed LC-MS/MS technique
- A green strategy for obtaining anthraquinones from Rheum tanguticum by subcritical water
- Cadmium (Cd) chloride affects the nutrient uptake and Cd-resistant bacterium reduces the adsorption of Cd in muskmelon plants
- Removal of H2S by vermicompost biofilter and analysis on bacterial community
- Structural cytotoxicity relationship of 2-phenoxy(thiomethyl)pyridotriazolopyrimidines: Quantum chemical calculations and statistical analysis
- A self-breaking supramolecular plugging system as lost circulation material in oilfield
- Synthesis, characterization, and pharmacological evaluation of thiourea derivatives
- Application of drug–metal ion interaction principle in conductometric determination of imatinib, sorafenib, gefitinib and bosutinib
- Synthesis and characterization of a novel chitosan-grafted-polyorthoethylaniline biocomposite and utilization for dye removal from water
- Optimisation of urine sample preparation for shotgun proteomics
- DFT investigations on arylsulphonyl pyrazole derivatives as potential ligands of selected kinases
- Treatment of Parkinson’s disease using focused ultrasound with GDNF retrovirus-loaded microbubbles to open the blood–brain barrier
- New derivatives of a natural nordentatin
- Fluorescence biomarkers of malignant melanoma detectable in urine
- Study of the remediation effects of passivation materials on Pb-contaminated soil
- Saliva proteomic analysis reveals possible biomarkers of renal cell carcinoma
- Withania frutescens: Chemical characterization, analgesic, anti-inflammatory, and healing activities
- Design, synthesis and pharmacological profile of (−)-verbenone hydrazones
- Synthesis of magnesium carbonate hydrate from natural talc
- Stability-indicating HPLC-DAD assay for simultaneous quantification of hydrocortisone 21 acetate, dexamethasone, and fluocinolone acetonide in cosmetics
- A novel lactose biosensor based on electrochemically synthesized 3,4-ethylenedioxythiophene/thiophene (EDOT/Th) copolymer
- Citrullus colocynthis (L.) Schrad: Chemical characterization, scavenging and cytotoxic activities
- Development and validation of a high performance liquid chromatography/diode array detection method for estrogen determination: Application to residual analysis in meat products
- PCSK9 concentrations in different stages of subclinical atherosclerosis and their relationship with inflammation
- Development of trace analysis for alkyl methanesulfonates in the delgocitinib drug substance using GC-FID and liquid–liquid extraction with ionic liquid
- Electrochemical evaluation of the antioxidant capacity of natural compounds on glassy carbon electrode modified with guanine-, polythionine-, and nitrogen-doped graphene
- A Dy(iii)–organic framework as a fluorescent probe for highly selective detection of picric acid and treatment activity on human lung cancer cells
- A Zn(ii)–organic cage with semirigid ligand for solvent-free cyanosilylation and inhibitory effect on ovarian cancer cell migration and invasion ability via regulating mi-RNA16 expression
- Polyphenol content and antioxidant activities of Prunus padus L. and Prunus serotina L. leaves: Electrochemical and spectrophotometric approach and their antimicrobial properties
- The combined use of GC, PDSC and FT-IR techniques to characterize fat extracted from commercial complete dry pet food for adult cats
- MALDI-TOF MS profiling in the discovery and identification of salivary proteomic patterns of temporomandibular joint disorders
- Concentrations of dioxins, furans and dioxin-like PCBs in natural animal feed additives
- Structure and some physicochemical and functional properties of water treated under ammonia with low-temperature low-pressure glow plasma of low frequency
- Mesoscale nanoparticles encapsulated with emodin for targeting antifibrosis in animal models
- Amine-functionalized magnetic activated carbon as an adsorbent for preconcentration and determination of acidic drugs in environmental water samples using HPLC-DAD
- Antioxidant activity as a response to cadmium pollution in three durum wheat genotypes differing in salt-tolerance
- A promising naphthoquinone [8-hydroxy-2-(2-thienylcarbonyl)naphtho[2,3-b]thiophene-4,9-dione] exerts anti-colorectal cancer activity through ferroptosis and inhibition of MAPK signaling pathway based on RNA sequencing
- Synthesis and efficacy of herbicidal ionic liquids with chlorsulfuron as the anion
- Effect of isovalent substitution on the crystal structure and properties of two-slab indates BaLa2−xSmxIn2O7
- Synthesis, spectral and thermo-kinetics explorations of Schiff-base derived metal complexes
- An improved reduction method for phase stability testing in the single-phase region
- Comparative analysis of chemical composition of some commercially important fishes with an emphasis on various Malaysian diets
- Development of a solventless stir bar sorptive extraction/thermal desorption large volume injection capillary gas chromatographic-mass spectrometric method for ultra-trace determination of pyrethroids pesticides in river and tap water samples
- A turbidity sensor development based on NL-PI observers: Experimental application to the control of a Sinaloa’s River Spirulina maxima cultivation
- Deep desulfurization of sintering flue gas in iron and steel works based on low-temperature oxidation
- Investigations of metallic elements and phenolics in Chinese medicinal plants
- Influence of site-classification approach on geochemical background values
- Effects of ageing on the surface characteristics and Cu(ii) adsorption behaviour of rice husk biochar in soil
- Adsorption and sugarcane-bagasse-derived activated carbon-based mitigation of 1-[2-(2-chloroethoxy)phenyl]sulfonyl-3-(4-methoxy-6-methyl-1,3,5-triazin-2-yl) urea-contaminated soils
- Antimicrobial and antifungal activities of bifunctional cooper(ii) complexes with non-steroidal anti-inflammatory drugs, flufenamic, mefenamic and tolfenamic acids and 1,10-phenanthroline
- Application of selenium and silicon to alleviate short-term drought stress in French marigold (Tagetes patula L.) as a model plant species
- Screening and analysis of xanthine oxidase inhibitors in jute leaves and their protective effects against hydrogen peroxide-induced oxidative stress in cells
- Synthesis and physicochemical studies of a series of mixed-ligand transition metal complexes and their molecular docking investigations against Coronavirus main protease
- A study of in vitro metabolism and cytotoxicity of mephedrone and methoxetamine in human and pig liver models using GC/MS and LC/MS analyses
- A new phenyl alkyl ester and a new combretin triterpene derivative from Combretum fragrans F. Hoffm (Combretaceae) and antiproliferative activity
- Erratum
- Erratum to: A one-step incubation ELISA kit for rapid determination of dibutyl phthalate in water, beverage and liquor
- Review Articles
- Sinoporphyrin sodium, a novel sensitizer for photodynamic and sonodynamic therapy
- Natural products isolated from Casimiroa
- Plant description, phytochemical constituents and bioactivities of Syzygium genus: A review
- Evaluation of elastomeric heat shielding materials as insulators for solid propellant rocket motors: A short review
- Special Issue on Applied Biochemistry and Biotechnology 2019
- An overview of Monascus fermentation processes for monacolin K production
- Study on online soft sensor method of total sugar content in chlorotetracycline fermentation tank
- Studies on the Anti-Gouty Arthritis and Anti-hyperuricemia Properties of Astilbin in Animal Models
- Effects of organic fertilizer on water use, photosynthetic characteristics, and fruit quality of pear jujube in northern Shaanxi
- Characteristics of the root exudate release system of typical plants in plateau lakeside wetland under phosphorus stress conditions
- Characterization of soil water by the means of hydrogen and oxygen isotope ratio at dry-wet season under different soil layers in the dry-hot valley of Jinsha River
- Composition and diurnal variation of floral scent emission in Rosa rugosa Thunb. and Tulipa gesneriana L.
- Preparation of a novel ginkgolide B niosomal composite drug
- The degradation, biodegradability and toxicity evaluation of sulfamethazine antibiotics by gamma radiation
- Special issue on Monitoring, Risk Assessment and Sustainable Management for the Exposure to Environmental Toxins
- Insight into the cadmium and zinc binding potential of humic acids derived from composts by EEM spectra combined with PARAFAC analysis
- Source apportionment of soil contamination based on multivariate receptor and robust geostatistics in a typical rural–urban area, Wuhan city, middle China
- Special Issue on 13th JCC 2018
- The Role of H2C2O4 and Na2CO3 as Precipitating Agents on The Physichochemical Properties and Photocatalytic Activity of Bismuth Oxide
- Preparation of magnetite-silica–cetyltrimethylammonium for phenol removal based on adsolubilization
- Topical Issue on Agriculture
- Size-dependent growth kinetics of struvite crystals in wastewater with calcium ions
- The effect of silica-calcite sedimentary rock contained in the chicken broiler diet on the overall quality of chicken muscles
- Physicochemical properties of selected herbicidal products containing nicosulfuron as an active ingredient
- Lycopene in tomatoes and tomato products
- Fluorescence in the assessment of the share of a key component in the mixing of feed
- Sulfur application alleviates chromium stress in maize and wheat
- Effectiveness of removal of sulphur compounds from the air after 3 years of biofiltration with a mixture of compost soil, peat, coconut fibre and oak bark
- Special Issue on the 4th Green Chemistry 2018
- Study and fire test of banana fibre reinforced composites with flame retardance properties
- Special Issue on the International conference CosCI 2018
- Disintegration, In vitro Dissolution, and Drug Release Kinetics Profiles of k-Carrageenan-based Nutraceutical Hard-shell Capsules Containing Salicylamide
- Synthesis of amorphous aluminosilicate from impure Indonesian kaolin
- Special Issue on the International Conf on Science, Applied Science, Teaching and Education 2019
- Functionalization of Congo red dye as a light harvester on solar cell
- The effect of nitrite food preservatives added to se’i meat on the expression of wild-type p53 protein
- Biocompatibility and osteoconductivity of scaffold porous composite collagen–hydroxyapatite based coral for bone regeneration
- Special Issue on the Joint Science Congress of Materials and Polymers (ISCMP 2019)
- Effect of natural boron mineral use on the essential oil ratio and components of Musk Sage (Salvia sclarea L.)
- A theoretical and experimental study of the adsorptive removal of hexavalent chromium ions using graphene oxide as an adsorbent
- A study on the bacterial adhesion of Streptococcus mutans in various dental ceramics: In vitro study
- Corrosion study of copper in aqueous sulfuric acid solution in the presence of (2E,5E)-2,5-dibenzylidenecyclopentanone and (2E,5E)-bis[(4-dimethylamino)benzylidene]cyclopentanone: Experimental and theoretical study
- Special Issue on Chemistry Today for Tomorrow 2019
- Diabetes mellitus type 2: Exploratory data analysis based on clinical reading
- Multivariate analysis for the classification of copper–lead and copper–zinc glasses
- Special Issue on Advances in Chemistry and Polymers
- The spatial and temporal distribution of cationic and anionic radicals in early embryo implantation
- Special Issue on 3rd IC3PE 2020
- Magnetic iron oxide/clay nanocomposites for adsorption and catalytic oxidation in water treatment applications
- Special Issue on IC3PE 2018/2019 Conference
- Exergy analysis of conventional and hydrothermal liquefaction–esterification processes of microalgae for biodiesel production
- Advancing biodiesel production from microalgae Spirulina sp. by a simultaneous extraction–transesterification process using palm oil as a co-solvent of methanol
- Topical Issue on Applications of Mathematics in Chemistry
- Omega and the related counting polynomials of some chemical structures
- M-polynomial and topological indices of zigzag edge coronoid fused by starphene